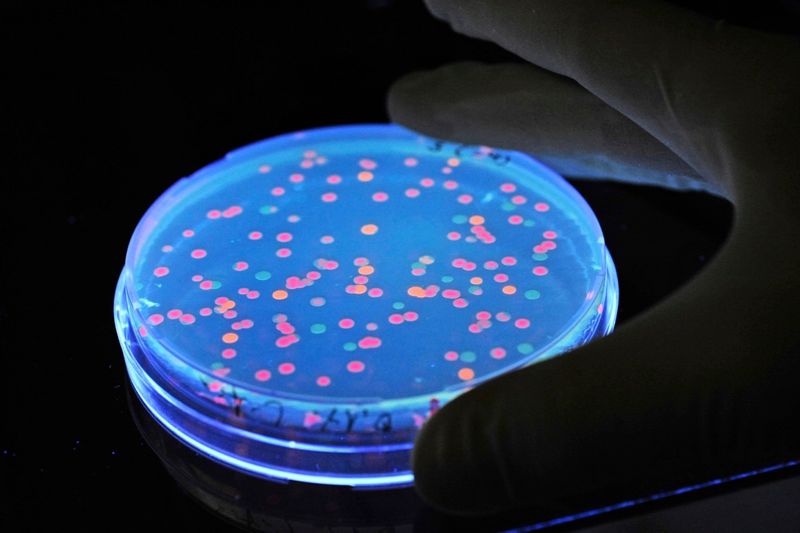
Österreicher vertrauen der Wissenschaft – aber nicht allen Disziplinen

Pandemie
Hier erscheinen automatisert Artikel zum Thema Pandemie aus den öffentlichen Quellen.
RSS Feed
Ernteausfälle, Pandemie: Wie sorgt Österreich für Lebensmittelengpässe vor?
www.derstandard.at | 2026-02-27 05:00:00
#österreich #pandemieLieferketten sind fragil, das hat die Corona-Pandemie gezeigt. Lebensmittel wurden teilweise knapp. Aber anders als in anderen Ländern denkt man in Österreich erst jetzt über staatliche Lebensmittelvorräte nach

Friseure in Niedersachsen gehen gegen Corona-Rückzahlungen auf die Barrikaden
www.ostsee-zeitung.de | 2026-02-11 17:32:16
#niedersachsen #pandemieDie Friseure in Niedersachsen argumentieren: Die Unterstützung des Landes während der Pandemie war nie als Kredit gekennzeichnet – Rückzahlungen waren explizit nicht Teil der Verträge. Jetzt wollen sie eine Petition starten.

EU will mit Melde-App gegen Cybermobbing vorgehen
www.tagesschau.de | 2026-02-10 20:16:41
#eu #eukommission #pandemie #internetDie EU-Kommission nennt es eine "Pandemie": Etwa jedes sechste Kind in der EU ist von Hass und Mobbing im Internet betroffen. Nun geht die Kommission das Problem mit einem Aktionsplan an und verspricht eine Melde-App.

Rostockerin trotzt seit 20 Jahren Ladensterben - doch auch sie dachte ans Aufhören
www.ostsee-zeitung.de | 2026-02-10 15:52:19
#pandemieGröße, Passform, das richtige Modell: Anna Bondar (47) weiß alles über Damenwäsche. Seit fast 20 Jahren führt sie ihr kleines Fachgeschäft im Hopfenmarkt. Pandemie, steigende Kosten – vieles hätte ihren Laden beenden können. Doch sie hält durch.

Fluggastzahlen 2025: Warum sich deutsche Inlandsflüge noch immer nicht erholt haben
www.berliner-zeitung.de | 2026-01-29 13:54:10
#deutschland #pandemieDie Passagierzahlen an deutschen Flughäfen steigen. Während internationale Verbindungen fast wieder auf Normalniveau sind, hat sich der innerdeutsche Flugverkehr seit der Pandemie halbiert.

Massengrab liefert Beweis für die Tödlichkeit der Justinianischen Pest
www.derstandard.at | 2026-01-23 05:00:00
#pandemieDie spätantike Pandemie raffte im Byzantinischen Reich womöglich Millionen Menschen dahin. Ein neuer Fund in Jordanien zeigt, dass die Seuche auch größere Städte an ihre Grenzen brachte

Virologe Streeck: Haben einigen Menschen in der Corona-Pandemie „Unrecht angetan“
www.ostsee-zeitung.de | 2026-01-20 17:20:11
#pandemieDruck auf Ungeimpfte und Schulschließungen: Der Virologe Hendrik Streeck kritisiert Entscheidungen in der Corona-Pandemie. Doch kommt man fehlerfrei durch solche Krisen? Oder ist Unrecht unvermeidbar?

Eventim: Pandemie - Vergleich mit Verbraucherschutz bringt 20-Euro-Gutschein für Sammelkläger
www.spiegel.de | 2026-01-15 17:04:00
#pandemieWer zu Pandemiezeiten Eventim-Tickets besessen hat, war in vielen Fällen gleich zweimal frustriert: wegen abgesagter Veranstaltungen und nicht erstatteter Gebühren. 5000 Verbraucher klagten. Und bekommen jetzt einen Gutschein.
Maskenaffäre: Gericht verhandelt wegen Steuerhinterziehung in Millionenhöhe
www.zeit.de | 2026-01-15 14:38:32
#gericht #münchen #pandemie #bayernEin Unternehmer soll in der Pandemie fünf Millionen Masken verkauft haben. Weil er den Gewinn offenbar nicht versteuerte, steht er in Bayern vor Gericht.
Maskenaffäre: Gericht verhandelt wegen Steuerhinterziehung in Millionenhöhe
www.zeit.de | 2026-01-15 14:38:32
#gericht #pandemie #bayernEin Unternehmer soll in der Pandemie fünf Millionen Masken verkauft haben. Weil er den Gewinn offenbar nicht versteuerte, steht er in Bayern vor Gericht.

Hannover: Mehrjährige Haftstrafe für Betreiber von Corona-Testzentrum
www.spiegel.de | 2026-01-14 12:01:00
#pandemie #gerichtDas Amtsgericht Hannover hat einen Mann wegen Betrugs verurteilt, der in der Pandemie offenbar Hunderttausende Euro zu viel abgerechnet hat. Vor Gericht räumte er die Taten ein.

Wie ein Vierteljahrhundert der Krisen den liberalen Traum zerbersten ließ
www.derstandard.at | 2026-01-10 06:00:00
#pandemie #donaldtrump #putinAm 1. Jänner 2000 war die Welt voller Hoffnung auf eine bessere Zukunft. Terror, Finanzkrise, Flüchtlingsdramen, Pandemie, Putin und Trump brachten uns in die triste Gegenwart

Armut in Rio: SPIEGEL-Leser verändert Leben von Zwillingen in der Maré
www.spiegel.de | 2026-01-04 16:50:00
#pandemieIn der Maré, Rio de Janeiros gefährlichem Armenviertel, drohten Zwillingsschwestern während der Pandemie den Anschluss zu verlieren. Dann meldete sich ein SPIEGEL‑Leser.

Corona-Pandemie: Wenn das Kindeswohl fatalerweise aus dem Blick gerät
www.berliner-zeitung.de | 2026-01-02 20:15:38
#pandemie #gerichtUnter dem Eindruck der Pandemie geht unsere Autorin mit den Organisationen, die sich dem Schutz von Kindern besonders verpflichtet fühlen sollten, hart ins Gericht.

Corona: Fallzahlen auf einer interaktiven Karte
www.abendblatt.de | 2026-01-01 06:48:00
#deutschland #pandemie #coronaDie aktuell gemeldeten Fallzahlen für Deutschland, die Bundesländer und Kreise - und die Pandemie von 2020 bis 2023 weltweit im Zeitverlauf.

Brasilien: Altinha bringt Gemeinschaft zurück an Rios Strände
www.spiegel.de | 2025-12-27 16:55:00
#pandemieEin Strandspiel erobert meine Heimatstadt: Altinha. Kein Wettkampf, kein Sieger – nur Sonne, Sand und Menschen, die gemeinsam einen Ball in der Luft halten. Das hat Rio nach den Jahren von Pandemie und Bolsonaro gebraucht.

Forscher modellieren Vogelgrippe-Pandemie bei Menschen – „Gefahr ist real“
www.abendblatt.de | 2025-12-27 16:51:19
#pandemieDie Vogelgrippe infiziert meist Vögel, doch immer wieder auch Menschen. Nun haben Forscher untersucht, ob es zu einer Pandemie kommen könnte.

Jerry Bruckheimer: Produzent von »F1« und »Top Gun: Maverick« verrät sein Erfolgsgeheimnis
www.spiegel.de | 2025-12-26 20:32:00
#pandemieDas Kino hat Long Covid, seit der Pandemie ist Krise. Rettet ausgerechnet ein 82-Jähriger Hollywood? Jerry Bruckheimer pfeift auf Computereffekte, und seine Filme spielen Milliarden ein. Hier erklärt er sein Erfolgsrezept.
Auswanderung aus Deutschland: Aber gehören sie noch hierher?
www.zeit.de | 2025-12-25 20:01:48
#deutschland #pandemieIn der Pandemie verließen Sabine und Maik Deutschland, voller Misstrauen und Wut. Jetzt sind sie zurück. Und fragen sich, was sie noch mit ihrer Heimat verbindet.
Österreicher vertrauen der Wissenschaft – aber nicht allen Disziplinen
www.derstandard.at | 2025-12-19 17:00:00
#pandemie #österreichDie neuen Werte des Wissenschaftsbarometers zeigen hohe Vertrauenswerte für die Wissenschaft in Österreich. Die Skepsis während der Pandemie scheint überwunden

Hendrik Streeck im SPIEGEL-Talk: »In einigen Milieus ist es fast normal geworden, Kokain zu konsumieren«
www.spiegel.de | 2025-12-17 23:04:00
#pandemieEr war der Rebell unter den Virologen, jetzt ist er Drogenbeauftragter der Bundesregierung. Hier spricht Neupolitiker Hendrik Streeck über Koks-Taxis, seine Lehren aus der Pandemie und darüber, ob 98-Jährige noch neue Hüftgelenke brauchen.

Hendrik Streeck im SPIEGEL-Talk: »In einigen Milieus ist es fast normal geworden, Kokain zu konsumieren«
www.spiegel.de | 2025-12-17 20:43:00
#pandemieEr war der Rebell unter den Virologen, jetzt ist er Drogenbeauftragter der Bundesregierung. Hier spricht Neupolitiker Hendrik Streeck über Koks-Taxis, seine Lehren aus der Pandemie und ob 98-Jährige noch neue Hüftgelenke brauchen.

Warum Sachsen-Anhalt Corona-Notlage ausruft, obwohl alles normal ist
www.berliner-zeitung.de | 2025-12-17 19:48:21
#sachsenanhalt #corona #pandemieDie Pandemie ist beendet, der Ausnahmezustand nicht: Sachsen-Anhalt erklärt Corona auch 2026 zur Notlage und setzt die Schuldenbremse erneut außer Kraft. Doch hält dieses Vorgehen einer verfassungsrechtlichen Prüfung stand?
Corona-Pademie: Jens Spahn verteidigt milliardenschwere Maskenkäufe im Bundestag
www.zeit.de | 2025-12-15 17:20:10
#bundestag #pandemieDas Gesundheitsministerium hat während der Pandemie gegen den Rat von Fachabteilungen in großem Umfang Masken gekauft. Nun verteidigte Spahn sich dafür vor dem Bundestag.

Vor Befragung in Enquete-Kommission: Ex-Gesundheitsminister Spahn verteidigt Maskenbeschaffung
www.berliner-zeitung.de | 2025-12-15 09:48:13
#pandemieJens Spahn hat eingeräumt, bei der Maskenbeschaffung nicht dem Vergaberecht gefolgt zu sein. Er wird sich an diesem Montag in der Kommission zur Aufarbeitung der Pandemie äußern.

Trotz drohender Milliardenschäden: Spahn verteidigt seine Maskenpolitik während der Pandemie
www.spiegel.de | 2025-12-15 09:38:00
#pandemie #bundestagEx-Gesundheitsminister Spahn steht wegen der Beschaffung von Masken während der Pandemie unter Druck und muss vor der Enquete-Kommission im Bundestag auftreten. Nun hat er sein Vorgehen öffentlich gerechtfertigt.

Corona: Jens Spahn verteidigt seine Maskenpolitik während der Pandemie
www.spiegel.de | 2025-12-15 09:38:00
#pandemie #bundestag #coronaEx-Gesundheitsminister Spahn steht wegen der Beschaffung von Masken während der Pandemie unter Druck und muss vor der Enquete-Kommission im Bundestag auftreten. Nun hat er sein Vorgehen öffentlich gerechtfertigt.

Immer mehr Hamburger Grundschulkinder erwerben Seepferdchen
www.abendblatt.de | 2025-12-14 10:52:00
#pandemieViele Kinder tragen es stolz auf Badeanzug oder Badehose: das Seepferdchen. Rückstände aus Pandemie aufgeholt. DLRG verzeichnet Höchstwert.
Zinsentscheid: US-Notenbank senkt Leitzins zum dritten Mal in Folge
www.zeit.de | 2025-12-10 23:59:36
#donaldtrump #pandemie #uspräsidentErstmals seit der Pandemie liegt der US-Leitzins wieder bei 3,5 bis 3,75 Prozent. US-Präsident Donald Trump kritisiert die Fed als zu zögerlich.

DSW-Erhebung: Virtuelle Hauptversammlungen kommen nicht gut an
www.tagesschau.de | 2025-12-10 12:12:47
#pandemieDie Pandemie hat auch in die Aktienkultur eingegriffen. Jährliche Hauptversammlungen konnten seitdem virtuell abgehalten werden. Viele Konzerne kehren mittlerweile zögerlich zur alten Praxis zurück, zeigt ein Report der DSW.

Weihnachtsurlaub: 43 Prozent für die Arbeit erreichbar
www.heise.de | 2025-12-10 12:09:00
#pandemieLaut Bitkom-Studie sind dieses Jahr 43 Prozent der Berufstätigen trotz Weihnachtsurlaub dienstlich erreichbar – deutlich weniger als noch vor der Pandemie.

Merkel über Corona-Pandemie: „War eine demokratische Zumutung“
www.ostsee-zeitung.de | 2025-12-09 21:52:19
#pandemieDie Ex-Kanzlerin blickt zurück auf die schwierige Zeit der Pandemie. Eine riesige Herausforderung sei es für sie gewesen, erklärt Merkel – man habe von Menschen verlangt, nicht menschlich zu sein.
Altkanzlerin: Angela Merkel erhält Auszeichnung für Einsatz in der Coronapandemie
www.zeit.de | 2025-12-09 20:14:50
#pandemieFür ihre Coronapolitik erhält Altkanzlerin Angela Merkel die baden-württembergische Staufermedaille. Merkel bezeichnete die Pandemie als "eine demokratische Zumutung".

Angela Merkel: Coronapandemie war eine »demokratische Zumutung«
www.spiegel.de | 2025-12-09 20:09:00
#pandemie #stuttgartIn Stuttgart wird Angela Merkel für ihre Coronapolitik ausgezeichnet. Dabei findet die Ex-Kanzlerin auch kritische Worte: Man habe in der Pandemie »von den Menschen verlangt, sich nicht menschlich zu verhalten«.

Seepferdchen und Co.: Mehr Hamburger Grundschulkinder können schwimmen
www.abendblatt.de | 2025-12-07 13:37:00
#pandemieViele Kinder tragen es stolz auf Badeanzug oder Badehose: das Seepferdchen. Rückstände aus Pandemie aufgeholt. DLRG verzeichnet Höchstwert.

Warum Großeltern, Eltern und Enkel immer öfter gemeinsam urlauben
www.derstandard.at | 2025-12-07 07:00:00
#pandemieSpätestens seit der Pandemie boomen Mehrgenerationenreisen. Teure Urlaube sind längst nicht nur mehr Familientreffen für die Reichen und Schönen
"Copsy-Studie": Junge Menschen weiter stärker psychisch belastet als vor Pandemie
www.zeit.de | 2025-12-04 18:16:29
#pandemieAuch Jahre nach dem letzten Lockdown nehmen laut einer Studie mehr junge Menschen psychische Belastungen wahr als vor der Pandemie. Vor allem Mädchen sind betroffen.

Pest in Europa im Mittelalter: Vulkanausbruch trug offenbar zu Pandemie bei
www.spiegel.de | 2025-12-04 17:53:00
#europa #pandemieDer Schwarze Tod im 14. Jahrhundert kostete Millionen Menschen in Europa das Leben. Forscher haben rekonstruiert, wie sich die Pest so gut ausbreiten konnte und was ein vermutlicher Vulkanausbruch damit zu tun hatte.

Sachsen-Anhalt will für 2026 Corona-Notlage ausrufen: Um Schuldenbremse zu umgehen
www.berliner-zeitung.de | 2025-12-02 14:24:23
#sachsenanhalt #pandemieSeit Jahren ruft die Landesregierung eine „außergewöhnlichen Notsituation“ mit Bezug auf die Pandemie aus. Das Vorgehen folgt einer Strategie.
Pandemie: Millionenbetrug bei Corona-Hilfen: über sechs Jahre Haft
www.zeit.de | 2025-11-24 17:01:38
#pandemiePandemie: Corona-Kommission sieht schwere Fehler bei britischer Ex-Regierung
www.zeit.de | 2025-11-20 20:05:56
#pandemieEin Bericht zeigt drastische Fehler der britischen Ex-Regierung in der Pandemie. Im ersten Lockdown hätten aus Sicht der Kommission 23.000 Tote verhindert werden können.

Kritik an Boris Johnson: Großbritanniens Coronamaßnahmen kamen zu spät und waren nicht ausreichend
www.spiegel.de | 2025-11-20 18:21:00
#pandemie»Während der Pandemie herrschte im Zentrum der britischen Regierung eine toxische und chaotische Kultur«: Eine unabhängige Untersuchung äußert massive Kritik an Boris Johnsons Coronamaßnahmen.

Papst trifft Transpersonen zu Mittagessen im Vatikan
www.derstandard.at | 2025-11-15 15:18:13
#pandemieDie Pfarre des Küstenortes Torvaianica kümmert sich seit der Pandemie um die Gruppe von Transpersonen. Als "Geste der Aufnahme" werden sie mit Papst Leo XIV. speisen

„Corona-Schicksale“: Kurzgeschichten über die Pandemie und ihre gesellschaftlichen Folgen
www.berliner-zeitung.de | 2025-11-14 12:56:48
#pandemieDer Autor Eugen Zentner bietet in prägnanten Kurzgeschichten einen Blick auf die gesellschaftlichen Auswirkungen der Pandemie und die Spaltungen, die sie hinterließ.
Chronisches Fatigue Syndrom: Bundesregierung will Erforschung von ME/CFS stärker fördern
www.zeit.de | 2025-11-14 00:10:37
#pandemie #bundesregierungDie Zahl der Long-Covid- und ME/CFS-Erkrankungen hat seit der Pandemie stark zugenommen. Bis 2036 sollen deswegen 500 Millionen Euro in die Forschung investiert werden.

Biontech: Aktie fällt nach Bericht über Pfizer-Ausstieg
www.spiegel.de | 2025-11-13 18:50:00
#bericht #pandemieGemeinsam entwickelten Biontech und Pfizer den Coronaimpfstoff, um die Pandemie zu bekämpfen. Nun will Pfizer offenbar seine Anteile am Mainzer Vorzeigeunternehmen verkaufen. Die Börse reagierte prompt.

Corona: Wie Drosten und Wieler die Pandemie sehen
www.ostsee-zeitung.de | 2025-11-11 21:37:55
#thüringen #pandemie #coronaDrosten staunte über die geringe Immunität nach Erstinfektion, Wieler kritisiert späte Reaktionen vor Winterwellen. Ein Untersuchungsausschuss in Thüringen will Lehren aus der Corona-Pandemie ziehen.
Psychische Erkrankungen bei Jugendlichen: Sie sind noch nicht mal im Beruf und schon erschöpft
www.zeit.de | 2025-11-10 05:42:49
#pandemieDie Pandemie, Kriege und Klimakrise hinterlassen Spuren: Psychische Erkrankungen nehmen unter Jugendlichen stark zu. Mit ihnen steigen die Kosten für die Gesellschaft.
Aufarbeitung der Pandemie: Landtag: Experte kritisiert Corona-Politik scharf
www.zeit.de | 2025-11-07 13:47:37
#pandemie
Mark Zuckerberg: Illegale Privatschule in Palo Alto erzürnt Nachbarn
www.spiegel.de | 2025-11-07 12:06:00
#pandemieSchon in der Pandemie fielen die Elterntaxis auf, die am Anwesen des Meta-Gründers in Palo Alto vorfuhren. Ein Bericht zeigt nun, dass der Nachbarschaftsstreit im noblen Crescent Park noch weit länger zurückreicht.

An Ägyptens Pyramiden: „Größtes Museum in der Geschichte der Menschheit“ öffnet
www.ostsee-zeitung.de | 2025-11-04 13:37:52
#iran #pandemie #israelWirtschaftskrise, Pandemie und der Konflikt zwischen Israel und dem Iran – seit Jahren wird die offizielle Eröffnung des Grand Egyptian Museum verschoben. Jetzt gibt es endlich Klarheit.

Kurztrip nach Usedom: Strickend Entspannung finden mit Blick auf die Ostsee
www.berliner-zeitung.de | 2025-11-02 13:14:12
#pandemie #ostsee #usedom #berlinDie Strickcommunity des Berliner Labels Maschenfein, während der Pandemie online zusammengewachsen, entdeckt in Ahlbeck die Freuden des Analogen wieder.
Pandemie aufarbeiten: Landtag beschäftigt sich immer wieder mit Corona
www.zeit.de | 2025-03-10 04:00:38
#corona #pandemie
Psychische Gesundheit: Wie krank sind unsere Kinder wirklich?
www.spiegel.de | 2025-03-09 20:02:00
#pandemieViele Kinder und Jugendliche klagen über seelische Probleme. Fachleute erklären, wie ernst die Lage ist, welche Rolle die Folgen der Pandemie und die sozialen Medien spielen und was Betroffenen helfen kann.

Tourismus in Nordkorea: Warum Peter Gischke nie wieder dorthin reisen würde
www.ostsee-zeitung.de | 2025-03-08 06:00:04
#nordkorea #pandemieErstmals seit der Pandemie hat Nordkorea westliche Touristen wieder ins Land gelassen. Der Leipziger Rechtsanwalt Peter Gischke war vor knapp 10 Jahren in der abgeschotteten Diktatur und erklärt, warum er das heute nicht wieder machen würde.

Hamburgs Corona-Erklärer: „Das waren die größten Fehler“
www.abendblatt.de | 2025-03-08 06:00:00
#pandemieFünf Jahre nach Ausbruch der Pandemie analysiert Virologe Jonas Schmidt-Chanasit politische Strategien – und spricht über künftige Probleme.

MWC Barcelona: GSMA zufrieden mit 109.000 Besuchern
www.heise.de | 2025-03-06 19:45:00
#pandemieEs war wieder ganz schön voll: Nach Jahren der Pandemie hat sich der MWC Barcelona erholt. Die GSMA zeigt sich zufrieden mit der Messe, die viele Ableger hat.

Dauerkrise kostet die deutsche Wirtschaft 735 Milliarden Euro
www.spiegel.de | 2025-03-05 13:16:00
#deutschland #pandemieSeit 2020 steckt Deutschland in einer tiefen Krise. Die Folgen von Pandemie und Ukrainekrieg sowie andere geopolitische Verwerfungen kommen die Wirtschaft laut einer Berechnung des IW hierzulande teuer zu stehen.

Wie ist die Stimmung in der Tourismusbranche?
www.ndr.de | 2025-03-03 21:07:55
#pandemieDie Buchungslage ist fast auf dem Niveau vor der Pandemie: Zu Besuch auf dem Campingplatz Rostocker Heide in Graal-Müritz.

Von Krisen bis zum sechsten Kanzler: Van der Bellen hatte schon einiges zu tun
www.derstandard.at | 2025-03-03 10:13:25
#pandemieRegierungskrisen, Angelobungen, Pandemie: Bundespräsident Alexander Van der Bellen hat turbulente acht Jahre hinter sich. DER STANDARD gibt einen Überblick

Fahrradbranche: Wie Corona noch immer für massive Rabatte sorgt
www.ostsee-zeitung.de | 2025-02-28 11:05:49
#pandemie #coronaSpätfolgen der Pandemie machen Händlern und Herstellern noch immer zu schaffen. Und auch knauserige Kunden zwingen die Zweiradbranche zu Preissenkungen. Doch langfristig soll ein Gebrauchtmarkt für neue Impulse sorgen.

Luftfahrt: Wie sich das Geschäftsmodell der Airlines verändert
www.tagesschau.de | 2025-02-17 09:31:26
#deutschland #pandemieSeit der Pandemie profitiert die Luftfahrt vor allem von der Reiselust der Deutschen. Um das Geschäft mit dem Tourismus noch weiter auszubauen, hat Eurowings nun sogar einen eigenen Reiseveranstalter. Von Lilli-Marie Hiltscher.

Corona und die Folgen: Warum eine betreute Wohngemeinschaft für meinen Sohn nicht mehr infrage kommt
www.berliner-zeitung.de | 2025-02-15 06:21:25
#pandemie #coronaAn sich wollte unser Autorin ihren behinderten Sohn beim Umzug in eine WG unterstützen. Doch die Zustände während der Pandemie haben ihr Vertrauen erschüttert.

Corona-Pandemie führte zu mehr Ruhetagen in der Gastronomie
www.derstandard.at | 2025-02-13 06:55:53
#pandemie"Die Lockdowns waren augenöffnend" für viele Gastronomen, erklärt WKO-Gastronomieobmann Mario Pulker. Preisanstiege seien aber nicht nur der Pandemie geschuldet

Camp-Hill-Virus: Neuer Kandidat für die nächste Pandemie?
www.tagesschau.de | 2025-02-12 10:24:43
#pandemie #usaBei Spitzmäusen in den USA ist ein neues Virus entdeckt worden, manch ein Wissenschaftler äußert sich besorgt. Könnte es eine neue Pandemie auslösen? Von Frank Wittig.
Nahverkehr Deutschland: Fahrgastzahlen bei Bus und Bahn steigen wieder
www.zeit.de | 2025-02-10 14:02:05
#deutschland #pandemieIn der Pandemie nutzten weniger Menschen in Deutschland Bus und Bahn. Nun gehen die Zahlen wieder nach oben – auch wegen des Deutschlandtickets.

Fünf Jahre Corona: Die Pandemie ist längst nicht vorbei – werdet endlich erwachsen!
www.berliner-zeitung.de | 2025-02-08 17:36:09
#corona #pandemieKonflikte gehören zum Leben, aber wer Krisen lösen will, muss miteinander reden. Das klappt bei Corona nicht, weil wir uns von kindlichen Gefühlen beherrschen lassen.
Krankheitswelle: Sind gerade wirklich alle krank?
www.zeit.de | 2025-02-08 16:57:27
#pandemieKolleginnen, Lehrer und vor allem Kinder – alle haben die Grippe oder sind erkältet. Warum es dennoch nicht ungewöhnlich viele sind und ob die Pandemie noch schuld ist.

Virologe zu Corona: "Haben die gesellschaftliche Dynamik wohl unterschätzt"
www.derstandard.at | 2025-02-07 12:22:47
#pandemie #coronaAuch fünf Jahre nach Beginn der Pandemie beschäftigten uns ihre Folgen, gesundheitlich und gesellschaftlich. Man brauche einen gesellschaftlichen Konsens, sagen zwei Experten
Psychologie: Psychische Erkrankungen sind häufiger als früher. Stimmt´s?
www.zeit.de | 2025-02-07 10:25:34
#pandemieMehr Krankschreibungen als früher, das heißt nicht zwingend: mehr Erkrankungen. Doch eine Bevölkerungsgruppe macht Experten nicht erst seit der Pandemie zunehmend Sorgen.

Corona: Omikron – der Wendepunkt der Corona-Pandemie?
www.ostsee-zeitung.de | 2025-02-06 16:13:47
#pandemie #coronaMit jeder neuen Variante des Coronavirus hat sich die Pandemie verändert. Als sich Anfang 2022 zum Beispiel die Omikron-Variante ausbreitete, kam es zu einer spürbaren Entlastung in den Kliniken. Doch Omikron hatte weitere Folgen, wie eine Studie aus Katar zeigt.

Coronavirus: Wissen Sie noch, was Sie heute vor fünf Jahren gemacht haben?
www.spiegel.de | 2025-02-01 10:06:00
#pandemieAnfang 2020 begann die Pandemie. Ein Blick in unseren Familienchat bei WhatsApp zeigt, was wir damals schon wussten – und was noch nicht.
Flugverkehr: Nur halb so viele Fluggäste auf Inlandsflügen wie vor Corona
www.zeit.de | 2025-01-31 10:10:51
#pandemie #coronaIm innerdeutschen Flugverkehr gibt es seit der Pandemie weniger Passagiere. Laut Statistischem Bundesamt fliegen aber immer mehr Menschen.

Arbeitsmarkt: So stark ist Ihr Job von Krisen betroffen
www.spiegel.de | 2025-01-30 13:01:00
#pandemiePandemie, Ukrainekrieg, Inflation und Wirtschaftsflaute prägten die vergangenen Jahre. Wie haben sich die Krisen auf den Arbeitsmarkt ausgewirkt, wie hat sich Ihre Branche entwickelt? Der interaktive Überblick.

Bundestagswahl und Corona: Warum die Fehler der Pandemie Einfluss haben
www.ostsee-zeitung.de | 2025-01-28 18:30:05
#pandemie #bundestagswahl #deutschland #coronaDeutschland ist vergleichsweise gut durch die Pandemie gekommen. Doch die vielen Fehler der Politik haben dazu geführt, dass eine wachsende Zahl von Menschen das Vertrauen in die Demokratie verloren haben und sich Populisten und Extremisten zuwenden. Bei der Bundestagswahl werden die demokratischen…

Corona: Warum die Fehler der Pandemie-Politik die Bundestagswahl beeinflussen
www.ostsee-zeitung.de | 2025-01-28 17:57:12
#bundestagswahl #deutschland #pandemie #coronaDeutschland ist vergleichsweise gut durch die Pandemie gekommen. Doch die vielen Fehler der Politik haben dazu geführt, dass eine wachsende Zahl von Menschen das Vertrauen in die Demokratie verloren haben und sich Populisten und Extremisten zuwenden. Bei der Bundestagswahl werden die demokratischen…

BGH klärt, wann Stornokosten wegen Corona gezahlt werden müssen
www.tagesschau.de | 2025-01-28 15:31:22
#corona #pandemieZu Beginn der Pandemie stornierten viele Kunden ihre Pauschalreisen. Manche Veranstalter verlangten dafür Stornogebühren. Der Bundesgerichtshof stellte nun klar, unter welchen Voraussetzungen diese Gebühren anfallen. Von E. Hyseni.

Neuer Vogelgrippe-Fall beim Menschen gemeldet: Pandemie-Gefahr steigt
www.berliner-zeitung.de | 2025-01-27 21:45:06
#pandemie #großbritannienSelten infiziert sich ein Mensch mit der Vogelgrippe. Jetzt ist aber ein Fall in Großbritannien aufgetaucht. Forscher fürchten, dass das Virus eine Pandemie auslösen könnte.

Wäre Deutschland gut gewappnet für die nächste Pandemie?
www.tagesschau.de | 2025-01-27 12:35:41
#deutschland #pandemieMassentierhaltung, Reisen, globaler Handel und auch der Klimawandel begünstigen die Verbreitung von Krankheitserregern. Wie gut wäre Deutschland auf eine nächste Pandemie vorbereitet? Von Anette Kolb und Jonas Breitner.

Ökonomin Isabella Weber: »Höhere Staatsausgaben bremsen den Aufstieg der AfD«
www.spiegel.de | 2025-01-27 10:56:00
#deutschland #pandemieIn der Pandemie hat Deutschland wirtschaftspolitisch klug agiert – und dann den Vorteil verspielt, sagt die Forscherin Isabella Weber. Ihre Forderung an die künftige Regierung: mehr investieren und mehr Schulden machen.
Pandemie: Fünf Jahre Corona - Müssen wir uns noch Sorgen machen?
www.zeit.de | 2025-01-27 09:44:02
#pandemiePandemie: Streit um Corona-Soforthilfen: Über 1.400 Klagen anhängig
www.zeit.de | 2025-01-27 04:00:37
#pandemie
Die Pandemie ist vorbei, die Aufarbeitung noch nicht
www.abendblatt.de | 2025-01-26 19:45:00
#pandemieDen höchsten Preis haben die Kinder bezahlt. Wer jeden Kritiker von damals als Querdenker abtut, hat aus der Pandemie nichts gelernt.

Corona-Pandemie: Was bleibt, fünf Jahre nach den ersten Fällen?
www.spiegel.de | 2025-01-25 19:12:00
#corona #pandemieDie Pandemie ist beendet, aber das weltverändernde Virus gibt es auch heute noch. Mediziner und ein Long-Covid-Patient berichten, wie Corona ihr Leben und ihre Arbeit verändert hat.

Anthony Fauci: Donald Trump entzieht früherem Corona-Berater den Personenschutz
www.spiegel.de | 2025-01-24 21:24:00
#donaldtrump #pandemieSeit der Pandemie lebt der frühere Corona-Berater der US-Regierung gefährlich. Nun streicht Donald Trump ihm die Leibwächter des Secret Service: Fauci möge für seinen Schutz doch in Zukunft selbst zahlen.

Handys statt Applaus: Die trügerischen Reflexe des Theaterpublikums
www.derstandard.at | 2025-01-24 12:24:57
#pandemieHinaufklatschen oder aber gar nicht klatschen – Bekundungen des Publikums sind seit Social Media und Pandemie nicht mehr treffsicher einzuordnen

Robert F. Kennedy Jr. und die Gesundheitsbehörden: Und was, wenn die nächste Pandemie kommt?
www.spiegel.de | 2025-01-22 17:29:00
#pandemieDer Impfgegner Robert F. Kennedy Jr. soll die US-Gesundheitsbehörden entkernen und deren Mitarbeitende gefügig machen. Es könnte eine Blaupause für den Umgang mit anderen Beamtenapparaten werden. Und fatale Folgen haben.

Umstrittener Arzt spendet Millionensumme an die AfD
www.abendblatt.de | 2025-01-22 10:26:06
#pandemie #afdDer Spender sorgte in der Pandemie mit einem eigenen Impfstoff für Schlagzeilen. Es ist die wohl größte Spende der Parteigeschichte.

Lokales Gutscheinsystem: Bremehr läuft aus
www.weser-kurier.de | 2025-01-20 17:45:00
#pandemieWährend der Pandemie war das lokale Bezahlsystem Bremehr ein großer Erfolg. Doch mittlerweile hat es nicht mehr genügend Nutzer und wird deshalb eingestellt. Was das für Kundinnen und Kunden bedeutet.

Brände in Los Angeles, Krieg in Europa, Pandemie: Wie gehen wir mit Krisen um?
www.ostsee-zeitung.de | 2025-01-19 15:12:27
#interview #europa #pandemieGewappnet für jede Situation: Im Interview mit dem RedaktionsNetzwerk Deutschland spricht Katastrophenschutzforscher Henning Goersch über die Brände in Los Angeles, moderne Katastrophen und darüber, wie gut wir auf ein Worst-Case-Szenario vorbereitet wären.

Bayer-Personalvorständin: Telefonische Krankschreibung abschaffen
www.ostsee-zeitung.de | 2025-01-18 01:53:39
#pandemieWährend der Pandemie sei sie ein gutes Instrument gewesen, inzwischen hält die Personalvorständin des Bayer-Konzerns die telefonische Krankschreibung für unnötig. Zur Steigerung der Produktivität hält Heike Prinz aber eine breitere Debatte für notwendig.

So läuft Trumps Amtseinführung am 20. Januar ab
www.tagesschau.de | 2025-01-17 02:04:34
#donaldtrump #joebiden #pandemie #tvVor vier Jahren blieb Donald Trump der Amtseinführung von Joe Biden fern. Und wegen der Pandemie und strenger Sicherheitsvorkehrungen verfolgten viele Zuschauer die Zeremonie im TV. Diesmal soll es anders werden. Von Claudia Sarre.
Staatliche Hilfe: Was war die Soforthilfe in der Pandemie genau?
www.zeit.de | 2025-01-16 04:00:37
#pandemie
Krank im Job – warum es in Hamburg einen neuen Rekord gibt
www.abendblatt.de | 2025-01-13 14:33:07
#pandemie #hamburgZahl der Krankmeldungen hat sich bei großer Kasse binnen weniger Jahre fast verdoppelt. Beschäftigte fehlen länger als in der Pandemie.

Corona-Pandemie: Viel gelernt, aber nicht genug getan
www.tagesschau.de | 2025-01-11 17:05:05
#pandemie #deutschlandVor fünf Jahren begann die Corona-Pandemie. Weltweit starben sieben Millionen Menschen. Deutschland kam im Vergleich glimpflich davon, doch die Pandemie wirkt bis heute nach. Wären wir in Zukunft besser vorbereitet? Von Anke Hahn.
Vogelgrippe: Was bedeutet der erste Todesfall durch H5N1 in den USA?
www.zeit.de | 2025-01-07 16:56:49
#pandemie #usaErstmals ist in den USA ein Mensch an einer Infektion mit dem Vogelgrippevirus H5N1 gestorben. Der Beginn einer Pandemie ist das nicht. Doch der Fall ist Grund zur Sorge.

HMPV breitet sich in China aus: Ist das Virus ein Grund zur Sorge?
www.ostsee-zeitung.de | 2025-01-07 15:12:23
#china #pandemieHusten, Halsweh, Fieber: In Teilen Chinas kommt es momentan unter Kindern vergleichsweise oft zu solchen Symptomen. Das humane Metapneumovirus (HMPV) steht unter Verdacht. Der Beginn einer neuen Pandemie ist das aber nicht. Was über Ansteckungen und Erreger bekannt ist.

Kanada: Premier Justin Trudeau gibt auf
www.spiegel.de | 2025-01-07 12:55:00
#pandemieJustin Trudeau war in kürzester Zeit zum politischen Superstar aufgestiegen. Sein Rücktritt zeigt: Charisma und ein modernes Image allein reichen nicht aus, um ein Land durch Pandemie und Wirtschaftskrisen zu führen.

Kanada: Premier Justin Trudeau gibt auf - Das Ende von Mr. Nice Guy
www.spiegel.de | 2025-01-07 12:55:00
#pandemieJustin Trudeau war in kürzester Zeit zum politischen Superstar aufgestiegen. Sein Rücktritt zeigt: Charisma und ein modernes Image allein reichen nicht aus, um ein Land durch Pandemie und Wirtschaftskrisen zu führen.
Reisen: Reise-Schlichtungsstelle verzeichnet mehr Beschwerden als je zuvor
www.zeit.de | 2025-01-06 11:33:23
#pandemieNicht einmal während der Pandemie gab es so viele Beschwerden bei der Schlichtungsstelle Reise und Verkehr wie 2024. Der Großteil betraf erneut ausgefallene Flüge.

Delta-Variante: Wie eine Impfskeptikerin ihren Mann an Corona verlor
www.ostsee-zeitung.de | 2025-01-05 17:04:34
#corona #pandemieBianka Wieth sah die Maßnahmen zu Corona-Zeiten kritisch. Auch impfen lassen wollte sie sich nicht. Dann starb ihr Mann an dem Virus. Wie denkt sie heute, wo in der Politik die Aufarbeitung der Pandemie beginnt?

Kino 2025: Marktforscher rechnen mit Wachstum
stadt-bremerhaven.de | 2025-01-04 11:00:43
#pandemieDie Kinobranche hatte es in den letzten Jahren alles andere als leicht. Die Pandemie sorgte für eine ausgewachsene Krise und danach folgten dann die Autoren– und Schauspielerstreiks. Für 2025 sagen die Marktforscher der Firma Gower Street Analytics (via Deadline) ein...

EU wollte die Abhängigkeit von China reduzieren – gelungen ist das bisher nicht
www.derstandard.at | 2025-01-04 08:59:25
#eu #china #pandemieDie Pandemie hat gezeigt, wie schnell enge Lieferketten zum Problem werden. Die EU wollte sich aus dem Rachen des chinesischen Drachen befreien. Doch der Anteil Chinas an den Importen der EU steigt
Pandemie: China weist WHO-Kritik an Kooperation nach Corona zurück
www.zeit.de | 2024-12-31 12:45:49
#china #corona #pandemiePandemie: Fünf Jahre Corona: WHO wartet noch immer auf Daten aus China
www.zeit.de | 2024-12-30 19:53:29
#china #pandemieThomas Mertens: "Viele, die 'Aufarbeitung' sagen, wollen nur mit irgendwem ein Hühnchen rupfen"
www.zeit.de | 2024-12-30 15:57:31
#politik #pandemieEr geriet in die Kritik, weil die Stiko bei der Corona-Kinderimpfung zurückhaltend war. Hier spricht Thomas Mertens über seinen Umgang mit Druck während der Pandemie.

Konzerttickets werden immer teurer
www.derstandard.at | 2024-12-29 10:18:14
#münchen #pandemiePreise steigen zum einen als Folge der Pandemie, zum anderen setzen Großevents wie die Konzerte von Adele in München neue Maßstäbe

Warum die Nachwirkungen der Corona-Pandemie noch lange nicht überwunden sind
www.derstandard.at | 2024-12-28 06:00:00
#china #pandemieWas sich bei uns vor fünf Jahren mit einer Meldung über eine Lungenkrankheit in China ankündigte, wurde zur schlimmsten Pandemie seit über 100 Jahren – mit vielen Spätfolgen

Vatikan: Papst Franziskus hilft transsexuellen Prostituierten in Rom
www.spiegel.de | 2024-12-25 19:08:00
#pandemieSie leben in Hütten ohne Strom am Stadtrand von Rom, arbeiten als Prostituierte. Die Pandemie stürzte viele von ihnen in Hunger und Geldnot. Doch die Transsexuellen aus Lateinamerika haben überraschende Hilfe gefunden.

Papst Franziskus hilft transsexuellen Prostituierten in Rom
www.spiegel.de | 2024-12-25 19:08:00
#pandemieSie leben in Hütten ohne Strom am Stadtrand von Rom, arbeiten als Prostituierte. Die Pandemie stürzte viele von ihnen in Hunger und Geldnot. Doch die Transsexuellen aus Lateinamerika haben überraschende Hilfe gefunden.
Infektionskrankheiten: "Wir sind uns sicher: Krankheit X wird kommen"
www.zeit.de | 2024-12-25 17:34:44
#pandemieOstafrika ist ein Hotspot für Infektionskrankheiten. Wie Proben aus Kamelschlachthäusern die nächste Pandemie verhindern sollen, erklärt der Virologe Kariuki Njenga.

Der Pastor kommt per Kremser
www.weser-kurier.de | 2024-12-25 17:24:18
#pandemieWas in der Pandemie aus der Not heraus entstanden ist, ist nun schon eine kleine Tradition: Wie in Oberneuland an Heiligabend der Pfarrer per Kremser durch die Straßen fährt und zu den Menschen kommt.

Die Vogelgrippe darf keine neue Pandemie auslösen
www.weser-kurier.de | 2024-12-25 06:00:00
#pandemieNeue Fälle von Vogelgrippe führen zu Diskussionen um Impfungen fürs Geflügel. Die Forschung sollte auch eine Ansteckung von Menschen bedenken, meint Gerwin Möller.
Edwin Rosen: Achtsam ausrasten
www.zeit.de | 2024-12-22 19:08:47
#pandemieDas Popphänomen der Neuen Neuen Deutschen Welle ist besser als sein Name. Was als Krisensound der Pandemie begann, wird bei Musikern wie Edwin Rosen sogar zukunftsfähig.

Lil Wayne, Chris Brown: US-Stars sollen Corona-Hilfen in Millionenhöhe verschwendet haben
www.spiegel.de | 2024-12-20 13:16:00
#pandemieEin Hilfsfonds sollte US-Musikern helfen, die unter den Folgen der Pandemie litten. Musiker wie Chris Brown oder Lil Wayne haben die Gelder laut einem Bericht jedoch für Privatjets, Partys und Nacktmodels ausgegeben.
Aufarbeitung der Pandemie: Wer will noch über Corona reden?
www.zeit.de | 2024-12-18 15:19:37
#pandemie #coronaCorona ist vorbei, doch viele beschäftigt das Thema noch. Laut einer ZEIT-Umfrage fordern vor allem Arbeiter eine bessere Nachbearbeitung der Pandemie – und FDP-Wähler.
Mpox in Deutschland: Was die Schulschließung wegen der neuen Mpox-Variante bedeutet
www.zeit.de | 2024-12-17 19:46:02
#deutschland #pandemieErstmals muss in Deutschland eine Schule wegen des Mpox-Virus schließen. Das Virus droht eine Pandemie auszulösen. Ein Grund zur Sorge? Ja, aber anders als gedacht.

Die blau-schwarze Steiermark orientiert sich stark an Niederösterreich
www.derstandard.at | 2024-12-17 15:27:04
#pandemieGendersternverbot, Maßnahmen gegen den politischen Islam oder die Pandemie: FPÖ und ÖVP fordern in der Steiermark vieles, was in Niederösterreich schon umgesetzt wurde
Pandemie: Millionen-Betrug mit Corona-Tests: Viereinhalb Jahre Haft
www.zeit.de | 2024-12-16 14:42:43
#pandemie
Einsamkeit: Mehr als die Hälfte der jungen Menschen in Deutschland fühlt sich einsam
www.spiegel.de | 2024-12-16 06:35:00
#deutschland #pandemieJeder zweite junge Deutsche berichtet von moderater bis starker Einsamkeit: Eine Studie zeigt, dass Vereinsamung bei jungen Menschen auch nach der Pandemie anhält. Maßnahmen allerdings zielten vorwiegend auf Ältere.

Staatskrise in Rumänien: Pandemie des Hasses
www.spiegel.de | 2024-12-13 15:48:00
#russland #pandemie #rumänienIn Bukarest herrscht nach der kurzfristig annullierten Präsidentschaftswahl Aufruhr. Der Vormarsch rechtsextremer Parteien und die laut Geheimdienst von Russland gesteuerten hybriden Angriffe erschüttern das Land.

Immer mehr Firmen sind pleite. Sind noch Nachholeffekte aus der Pandemie dabei?
www.derstandard.at | 2024-12-11 15:26:06
#pandemieDer Kreditschutzverband KSV rechnet mit 6550 Insolvenzen bis Jahresende, die Schuldenberge wachsen in nie gesehene Höhen. Bald dürften weitere Pleiten hinzukommen, auch weil Covid-Hilfen auslaufen

Treibhausgase durch Tourismus innerhalb von 10 Jahren mehr als verdoppelt
www.ostsee-zeitung.de | 2024-12-11 14:45:49
#pandemieTourismus trug vor der Pandemie fast neun Prozent zum globalen Treibhausgas-Ausstoß bei. Die größte Herausforderung, um die CO2-Emissionen zu reduzieren, stellt dabei der Flugverkehr dar.

Studie: Junge Menschen in Deutschland trotz Krisen zufrieden
www.tagesschau.de | 2024-12-09 16:06:04
#deutschland #studie #pandemieSeit Ende der Pandemie geht es Kindern und Jugendlichen in Deutschland deutlich besser. Gleichzeitig sorgen sich laut einer Studie mehr junge Menschen um die Zukunft. Und jedes fünfte Kind erlebt Diskriminierung im Alltag. Von C. Álvarez.

Corona-Folgen: Warum junge Menschen psychisch stärker leiden
www.ostsee-zeitung.de | 2024-12-09 13:35:30
#pandemieKontaktbeschränkungen, Homeschooling und Ausgangssperren: Die unter 50-Jährigen tun sich schwerer damit als Ältere, die Pandemie und ihre Folgen psychisch wegzustecken. Bei frühere Krisen war das anders.

Jüngere Menschen erholen sich schlechter von Corona-Krisenjahren
www.ostsee-zeitung.de | 2024-12-09 13:32:04
#pandemieKontaktbeschränkungen, Homeschooling und Ausgangssperren: Die unter 50-Jährigen tun sich schwerer damit als Ältere, die Pandemie und ihre Folgen psychisch wegzustecken. Bei frühere Krisen war das anders.

Das Wundermittel, das Long Covid heilen sollte: Die irre Geschichte des Medikaments BC 007
www.berliner-zeitung.de | 2024-12-08 06:14:09
#pandemie #corona #berlinEin Berliner Start-up entwickelte ein Mittel für Herzkranke, schwenkte in der Pandemie auf Corona um, wollte plötzlich Long Covid heilen. Nun ist das Versprechen geplatzt – oder doch nicht?

Pandemie-Vorsorge: Genug Notvorräte für die nächste Pandemie? Fehlanzeige!
www.spiegel.de | 2024-12-06 18:56:00
#pandemieDer Staat wollte sich nicht noch einmal von einer Pandemie kalt erwischen lassen und deshalb Medikamente und Sanitätsartikel auf Vorrat anschaffen. Tatsächlich sind aber in vielen Bundesländern die Lager leer.

Corona-Zoff zwischen Drosten und Schmidt-Chanasit: „Ihr Verhalten ist hinterhältig“
www.berliner-zeitung.de | 2024-12-06 13:59:07
#hamburg #pandemie #berlinDer Virologe der Berliner Charité und sein Hamburger Kollege streiten heftig auf X. Es geht um Kinderimpfungen, Schulschließungen in der Pandemie – und noch viel mehr.

Corona-Pandemie: Laborthese »wahrscheinlich« - was genau in dem US-Abschlussbericht steht
www.spiegel.de | 2024-12-05 18:47:00
#donaldtrump #pandemieEin Untersuchungsausschuss des US-Repräsentantenhauses hat seinen Bericht zur Pandemie vorgelegt. Was nach einer sachlichen Aufarbeitung klingt, entpuppt sich als einseitige Abrechnung – mit Lob für Donald Trump.
Pandemie: Urteil zu Millionenbetrug mit Corona-Tests teils aufgehoben
www.zeit.de | 2024-12-05 17:08:34
#pandemie
Angela Merkel: »Freiheit. Erinnerungen 1954 – 2021« ist erfolgreichstes Buch des Jahres
www.spiegel.de | 2024-12-05 08:51:00
#deutschland #pandemieFlüchtlingskrise, Pandemie, ihr Aufstieg in der Union: Die Memoiren von Angela Merkel legten in der ersten Verkaufswoche einen besseren Start hin als jedes andere Buch in diesem Jahr.

Grundschüler in Mathe und Naturwissenschaften im Mittelfeld
www.tagesschau.de | 2024-12-04 12:51:07
#pandemie #deutschlandRechenkünstler oder Zahlenmuffel? Deutsche Grundschüler liegen in Mathematik und Naturwissenschaften im internationalen Vergleich im Mittelfeld, wie eine Studie zeigt. Große Abstürze gab es dieses Mal trotz Pandemie nicht.

Schulstudie lässt aufatmen, mehr aber auch nicht
www.abendblatt.de | 2024-12-04 10:30:28
#pandemieDie Kinder können so gut rechnen wie vor der Pandemie: immerhin. Allerdings steckt das eigentliche Problem wie einbetoniert im Bildungswesen fest.

Vogelgrippe in Kalifornien: Hunderte Kuhherden sind infiziert - der Anfang einer neuen Pandemie?
www.spiegel.de | 2024-12-03 15:58:00
#pandemieDie neuartige Vogelgrippe grassiert in Kalifornien. Hunderte Kuhherden sind infiziert, Tausende Tiere verendet. Ominöse Fälle von infizierten Kindern geben den Forschern Rätsel auf. Ist das der Anfang einer neuen Pandemie?
Arbeitszeit: Angestellte machen so wenige Überstunden wie noch nie
www.zeit.de | 2024-12-03 11:33:18
#deutschland #pandemieSeit der Pandemie sind die Überstunden der Arbeitnehmerinnen und Arbeitnehmer in Deutschland stark gefallen. Gleichzeitig arbeiten immer mehr Beschäftigte in Zweitjobs.

Corona-Ursprung: Virus stammt wohl aus Labor in Wuhan – US-Bericht
www.berliner-zeitung.de | 2024-12-03 09:11:09
#pandemieRepublikaner im Repräsentantenhaus: Pandemie ging wahrscheinlich von einem chinesischen Labor aus.
Pandemie: Fünf Jahre Corona - Müssen wir uns noch Sorgen machen?
www.zeit.de | 2024-12-03 02:00:37
#pandemieCorona: Kann die Herdenimmunität noch erreicht werden?
www.zeit.de | 2024-11-29 09:04:53
#pandemie #coronaWären genug Menschen gegen Covid immun, wäre die Pandemie vorbei. Ob Herdenimmunität realistisch ist und was das für die Delta-Variante bedeutet, zeigt unser Erklärvideo.

Lauterbach, das RKI und die Risikostufe: Corona-Maßnahmen als Erziehungsprogramm?
www.berliner-zeitung.de | 2024-11-29 05:53:22
#pandemieKarl Lauterbach lehnte im Februar 2022 den RKI-Vorschlag ab, die Corona-Risikostufe zu senken. Ein weiteres Detail aus der Pandemie mit Folgen. Ein Kommentar.

Überblick zu Corona-Jahren: Wann kam Maskenpflicht? Wann mussten Geschäfte schließen?
www.spiegel.de | 2024-11-28 19:26:00
#pandemieDie Pandemie hat unseren Alltag bestimmt, inzwischen verschwimmt vieles: Wann kam die Maskenpflicht? Wann mussten Geschäfte schließen? Und wie war das noch mit dem Lockdown Light? Der Überblick.

Corona-Pandemie: Hat Karl Lauterbach die Coronagefahr im Frühjahr 2022 überschätzt?
www.spiegel.de | 2024-11-28 19:23:00
#fdp #pandemieAufregung um das Krisenmanagement in der Pandemie: Vor zweieinhalb Jahren hinderte Gesundheitsminister Lauterbach das RKI, die Corona-Bewertung zu senken. War das ein Fehler? Die FDP fordert einen Untersuchungsausschuss.
Stefanie Stahl: Stefanie Stahl, was will das Kind in uns?
www.zeit.de | 2024-11-28 14:31:57
#podcast #pandemie #deutschlandDeutschlands bekannteste Psychologin spricht im Podcast über die Pandemie, Hausgeister und Psychotainment. Und sie verrät, warum Männer ihre schwierigste Zielgruppe sind.

Karl Lauterbach: Scharfe Kritik an Corona-Einflussnahme durch FDP und BSW
www.spiegel.de | 2024-11-28 12:22:00
#pandemieMindestens einmal überstimmte Gesundheitsminister Lauterbach einen Corona-Entscheid des RKI. Gegenüber dem SPIEGEL drängen BSW-Chefin Wagenknecht und FDP-Fraktionsgeschäftsführer Thomae nun auf Aufklärung.

"Dramatische Zahlen": Auch außerhalb Wiens wächst das Deutschproblem an Schulen
www.derstandard.at | 2024-11-26 16:09:11
#pandemieFlucht, Pandemie, Handyfixierung und Sparkurs: Wiens Bildungsstadtrat Wiederkehr sieht viele Gründe, warum so viele hier geborene Schulanfänger kein Deutsch können. Appelle richtet er quasi an sich selbst

Angela Merkel: Einblicke in Flüchtlingskrise, Pandemie und ihren Aufstieg in der Union
www.spiegel.de | 2024-11-26 13:38:00
#pandemieFlüchtlingskrise, Pandemie, ihr eigener Aufstieg in der Union: In ihren Memoiren gibt Angela Merkel Einblicke in die entscheidenden Phasen ihres politischen Lebens. Wie selbstkritisch ist sie dabei? Und was verrät sie Neues?

Angela Merkel: Memoiren über die Flüchtlingskrise, Pandemie und ihren Aufstieg in der Union
www.spiegel.de | 2024-11-26 13:38:00
#pandemieFlüchtlingskrise, Pandemie, ihr eigener Aufstieg in der Union: In ihren Memoiren gibt Angela Merkel Einblicke in die entscheidenden Phasen ihres politischen Lebens. Wie selbstkritisch ist sie dabei? Und was verrät sie Neues?

Klopapier, Kasse, Kondome: dm-Chef verrät, wie Deutsche einkaufen
www.abendblatt.de | 2024-11-26 06:25:00
#pandemie #deutschlanddm-Chef Christoph Werner spricht über das neue Ladenbild, Lehren aus der Pandemie – und wie viel Geld Eltern für ihr Baby bei dm ausgeben.

Klubnacht 20 Jahre Berghain – „500 Euro plus Flaschenservice“?
www.berliner-zeitung.de | 2024-11-22 12:15:09
#berlin #pandemieBerliner Clubs straucheln angesichts steigender Kosten. Auch das Berghain hat höhere Preise als noch vor der Pandemie. Doch jetzt überschlagen sich Gerüchte auf absurdem Level.

Mobilität: Reiseverhalten der Deutschen hat sich durch die Pandemie verändert
www.spiegel.de | 2024-11-22 11:24:00
#deutschland #pandemieDie Pandemie hat das Reiseverhalten der Deutschen stark verändert. Sie reisen weniger mit dem Auto, dafür mehr mit der Bahn. Vor allem Flugreisen im Inland gehen drastisch zurück.

Über 40.000 Spieler: Tennis boomt nach Corona auch in Hamburg
www.abendblatt.de | 2024-11-21 14:24:10
#corona #tennis #hamburg #pandemieSeit der Pandemie erlebt der Sport einen Aufschwung in der Stadt. 40.381 Aktive in 79 Vereinen. Aber manche Clubs haben Probleme.

Kommentar zu BGH-Urteil: Richter hat seine Macht missbraucht
www.tagesschau.de | 2024-11-20 21:02:30
#pandemieBewusst hat sich ein Familienrichter in Weimar während der Pandemie einen Fall ausgesucht - um Corona-Maßnahmen aussetzen zu können. Damit hat er das Vertrauen in Richter erschüttert, meint Philip Raillon. Das Urteil ist ein wichtiges Signal.

Kriminalstatistik: BKA-Chef warnt vor steigenden politischen Straftaten und Jugendkriminalität
www.spiegel.de | 2024-11-20 20:56:00
#pandemie #deutschlandDeutschland ist nicht mehr so sicher wie vor der Pandemie, sagt BKA-Chef Holger Münch und sieht dafür verschiedene Gründe. Die Entwicklung von Jugendkriminalität verdiene »höchste Aufmerksamkeit«.

Corona-Pandemie: BGH bestätigt Verurteilung von Amtsrichter wegen Masken-Entscheidung
www.zeit.de | 2024-11-20 16:09:38
#pandemieEin Amtsrichter hatte in der Pandemie das Maskenverbot an zwei Thüringer Schulen gekippt. Zu Unrecht, wie nun auch der Bundesgerichtshof entschieden hat.

Corona-Geständnis: Lauterbach bereut Kritik an Ungeimpften
www.abendblatt.de | 2024-11-19 02:01:39
#pandemieIm ARD-Talk werden politische Fehler während der Pandemie analysiert. Und der Gesundheitsminister streut Asche auf sein Haupt.

Trump-Funktionär: Corona ist in US-Biowaffen-Labor entstanden
www.abendblatt.de | 2024-11-19 01:17:11
#pandemie #coronaRobert Redfield, der frühere Chef der Seuchenschutzbehörde CDC, verblüfft fast fünf Jahre nach Ausbruch der Pandemie mit neuer These.

Singender Arzt aus Altefähr will Menschen mit seinen Songs zusammenbringen
www.ostsee-zeitung.de | 2024-11-15 19:43:11
#pandemieStefan Trzeczak aus Altefähr will Menschen nicht nur in der Notaufnahme helfen – sondern auch mit seiner Musik. Mit seinen tiefgründigen Texten will er der Spaltung der Gesellschaft entgegenwirken und Menschen aus ihren Blasen holen.
Nach der Pandemie: Bislang 150 Klagen wegen möglicher Corona-Impfschäden
www.zeit.de | 2024-11-15 16:00:40
#pandemie
Großbritanniens Hirsch-Problem: Jagd-Offensive soll zerstörerische Bestände eindämmen
www.ostsee-zeitung.de | 2024-11-14 16:31:28
#pandemieDie Bestände sind seit der Pandemie außer Kontrolle geraten. Die Zahl der Tiere ist so hoch, dass den Wäldern ernsthafter Schaden droht. Wildhüter plädieren für ihren Abschuss.

Hirschbestände in Großbritannien explodieren
www.ostsee-zeitung.de | 2024-11-14 16:20:50
#großbritannien #pandemieDie Bestände sind seit der Pandemie außer Kontrolle geraten. Die Zahl der Tiere ist so hoch, dass den Wäldern ernsthafter Schaden droht. Wildhüter plädieren ihren Abschuss.

Roland Wiesendanger und der Corona-Ursprung: Degradiert zum Verschwörungstheoretiker
www.berliner-zeitung.de | 2024-11-11 08:56:45
#pandemieDer Wissenschaftler ist seit Beginn der Pandemie überzeugt: Das Coronavirus stammt aus dem Labor. Er wurde deshalb hart angegangen – und könnte doch recht behalten.
Luftverkehr: Frankfurter Flughafen erholt sich schleppend von Pandemie
www.zeit.de | 2024-11-05 08:40:42
#pandemieAlkohol: Exzessiver Alkoholkonsum unter jungen Menschen nimmt zu
www.zeit.de | 2024-11-04 08:54:41
#pandemieRauschtrinken ist unter jungen Männern und Frauen wieder ähnlich verbreitet wie vor der Pandemie. Der Drogenbeauftragte kritisiert die ständige Verfügbarkeit von Alkohol.

Arbeit: So überzeugen Sie Ihren Arbeitgeber vom Homeoffice
www.ostsee-zeitung.de | 2024-11-03 11:06:31
#pandemieIm Homeoffice zu arbeiten, hat sich während der Pandemie oft als ideales Arbeitsmodell erwiesen. Doch längst nicht alle Arbeitgeber sind begeistert, wenn ihre Beschäftigten nun weiterhin mehr von zu Hause aus arbeiten wollen. Mit welchen Strategien Sie Ihre Führungskraft dennoch überzeugen.

Homeoffice: So kommen Sie an mehr Homeoffice-Tage
www.ostsee-zeitung.de | 2024-11-03 10:53:07
#pandemieIm Homeoffice zu arbeiten, hat sich während der Pandemie oft als ideales Arbeitsmodell erwiesen. Doch längst nicht alle Arbeitgeber sind begeistert, wenn ihre Beschäftigten nun weiterhin mehr von zu Hause aus arbeiten wollen. Mit welchen Strategien Sie Ihre Führungskraft dennoch überzeugen.

Hendrik Streeck vergleicht Corona-Ungeimpfte mit verfolgten Juden
www.ostsee-zeitung.de | 2024-11-02 11:21:59
#pandemieWährend der Corona-Krise war Hendrik Streeck ein viel befragter Virologe. In einem Interview kritisiert er jetzt den Umgang mit Ungeimpften während der Pandemie – und vergleicht sie mit Juden. Das sorgt für Kritik.
Ständige Impfkommission: "Wir müssen das Vertrauen wiederherstellen"
www.zeit.de | 2024-10-31 15:17:28
#pandemieWährend der Pandemie hat nicht nur das Vertrauen in Impfungen, sondern auch das in die Ständige Impfkommission gelitten. Ihr neuer Chef Reinhard Berner will das ändern.

Daten für 2022: Wo die Deutschen am zufriedensten sind
www.tagesschau.de | 2024-10-29 10:11:45
#deutschland #pandemieWährend der Pandemie ist die Zufriedenheit in Deutschland gesunken. Laut dem Bundesinstitut für Bevölkerungsforschung stiegen die Werte 2022 wieder. Dabei zeigten sich regionale Unterschiede - und auch Grünflächen spielten eine Rolle.

CaboCheck: Hamburger Top-Gastronom macht jetzt in Blut
www.abendblatt.de | 2024-10-26 06:10:00
#pandemie #hamburg #coronaWährend Corona bot er PCR-Tests an der Reeperbahn an. Wie ein Unternehmer Ideen und Technik aus der Pandemie in die Apotheken brachte.
Folge 39: März 2020: Die Coronapandemie
www.zeit.de | 2024-10-26 06:00:05
#donaldtrump #pandemieDie Coronakrise wird zur Pandemie. Es fehlt an Beatmungsgeräten, Krankenhausbetten und Masken. Donald Trump ruft den Notstand aus. Der März 2020

Wie die Impfkampagne gegen Corona die Geburtenzahlen beeinflusste
www.derstandard.at | 2024-10-24 05:00:00
#pandemie #coronaEin Wiener Forschungsteam liefert in seiner neuen Analyse zu Geburtenraten überraschende Ergebnisse über die Gründe, weshalb im Verlauf der Pandemie weniger Babys zur Welt kamen

Cybermobbing an Schulen: Angst, Alkohol, Suizidgedanken
www.spiegel.de | 2024-10-23 10:39:00
#pandemieFast jeder fünfte Jugendliche wurde schon online gemobbt – mit teils dramatischen Folgen bis hin zu Alkoholmissbrauch und Suizidgedanken. Das zeigt eine neue Umfrage. Seit der Pandemie hat das Problem massiv zugenommen.

Meilenstein für die Erforschung von ME/CFS: 700.000 Euro Förderung
www.derstandard.at | 2024-10-22 17:26:31
#pandemieDas Chronische Fatigue-Syndrom mit geschätzt 80.000 Betroffenen war vor der Pandemie weitgehend unbekannt. Jetzt wird die Forschung dazu massiv angekurbelt

Pet Shop Boy in Neukölln: Wenn Neil Tennant plötzlich im Heimathafen aufkreuzt und Musik empfiehlt
www.berliner-zeitung.de | 2024-10-21 13:26:41
#pandemie #berlinDie Pet Shop Boys lieben Berlin. Seit der Pandemie haben sie allerdings weniger Zeit hier verbracht. Nun hat Neil Tennant seine Berliner Fans überrascht.

Wohnungsnot: Forscherin will Problem mit leeren Gästezimmern lösen
www.ostsee-zeitung.de | 2024-10-19 18:50:08
#pandemie #australienWohnungssuchende haben es vor allem seit der Pandemie in vielen Ländern schwerer. Auch im fernen Australien wird Wohnraum immer unerschwinglicher, die Zahl der Obdachlosen wächst. Nun hat eine Forscherin einen Plan vorgelegt, der die moderne Gesellschaft zum Umdenken zwingt.

Maschinenbau in Deutschland: Stimmung kippt - Tiefpunkt nach Pandemie
www.ostsee-zeitung.de | 2024-10-19 11:16:35
#deutschland #pandemieÄrger mit dem Standort Deutschland, maue Auftragslage: Die Stimmung im Maschinenbau trübt sich weiter ein - und fällt sogar unter einen Tiefpunkt aus der Pandemie.

Umfrage: Stimmung im Maschinenbau in Deutschland kippt
www.ostsee-zeitung.de | 2024-10-19 07:47:01
#deutschland #pandemieÄrger mit dem Standort Deutschland, maue Auftragslage: Die Stimmung im Maschinenbau trübt sich weiter ein - und fällt sogar unter einen Tiefpunkt aus der Pandemie.
Pandemie: AfD will eigenen Corona-Untersuchungsausschuss im Landtag
www.zeit.de | 2024-10-16 14:06:04
#afd #pandemie
News: Corona-Impfungen, Deutsche Bahn, Sorgen um den Opel-Mutterkonzern
www.spiegel.de | 2024-10-16 05:40:00
#pandemieCorona rollt wieder durchs Land, die Pandemie und ihre Folgen sind noch immer nicht aufgearbeitet. Bei der Bahn gibt es Zoff. Und Opel steht vor einer ungewissen Zukunft. Das ist die Lage am Mittwochmorgen.

Bremer Freimarkt will sich nach der Pandemie voll erholt zeigen
www.weser-kurier.de | 2024-10-16 05:00:00
#pandemieAuf dem 989. Bremer Freimarkt können Besucher gleich in mehreren Fahrgeschäften hoch hinaus. Doch auch die Preise haben einen neuen Höhepunkt erreicht.

Bremer Freimarkt will sich nach der Pandemie voll erholt zeigen
www.weser-kurier.de | 2024-10-16 05:00:00
#pandemieAuf dem 989. Bremer Freimarkt können Besucher gleich in mehreren Fahrgeschäften hoch hinaus. Doch auch die Preise haben einen neuen Höhepunkt erreicht.

Lufthansa: Millionenstrafe in den USA wegen Diskriminierung von jüdischen Reisenden
www.spiegel.de | 2024-10-15 20:21:00
#pandemie #usaDie Lufthansa muss vier Millionen Dollar Strafe in den USA zahlen. Mitarbeiter hatten in der Pandemie über 100 jüdische Passagiere an der Weiterreise gehindert. US-Behörden sehen darin Diskriminierung.
Shell Jugendstudie: Die Generation Corona ist optimistisch
www.zeit.de | 2024-10-15 18:03:04
#corona #gazastreifen #israel #pandemieMenschen zwischen 12 und 25 blicken positiv in die Zukunft. Eine Erklärung der Shell Jugendstudie: Die Pandemie hat sie abgehärtet. Und: Israels Angriffe im Gazastreifen

Corona-Krise: Wie mich der Deutsche Schlager in der Pandemie rettete
www.berliner-zeitung.de | 2024-10-15 16:39:52
#deutschland #pandemieWährend der Pandemie hatte fast jeder ein Hobby. Unser Autor entdeckte Schlagerplatten und lernte, wie fortschrittlich und sexy der deutsche Schlager ist. Ein Bericht.
Pandemie: Lauterbach zu Corona: Aufarbeitung ohne Schuldzuweisungen
www.zeit.de | 2024-10-14 00:10:36
#corona #pandemie
Slowakische Regierung stellt Verbot von mRNA-Impfstoffen in den Raum
www.derstandard.at | 2024-10-12 11:18:02
#pandemieRegierungsbeauftragter Peter Kotlár, der die Unterstützung von Ministerpräsident Fico genießt, bezeichnet die Pandemie als "erfundene Operation"

Berlin: Was ich an der Kasse und beim Arzt über das Ende der Pandemie lernte
www.berliner-zeitung.de | 2024-10-11 15:13:51
#pandemie #berlinDer Herbst bringt nicht nur durchwachsenes Wetter, sondern auch zahlreiche Krankheitsfälle mit sich. Unser Kolumnist macht dabei eine spannende Beobachtung.

Drosten und die Umdeutung der Corona-Pandemie: Man wird ihm noch viel verzeihen müssen
www.berliner-zeitung.de | 2024-10-11 06:03:10
#pandemie„Die Umdeutung der Pandemie live mitverfolgen“: Charité-Virologe Christian Drosten behauptete in einem Interview, er habe nie eine Impfpflicht gefordert. Das stimmt nicht. Ein Kommentar.

Rückzahlung von Corona-Hilfen sorgt bei OZ-Lesern für Frust: „Das System macht die Kleinen kaputt“
www.ostsee-zeitung.de | 2024-10-10 16:42:34
#pandemie #mecklenburgvorpommernDie Corona-Soforthilfen müssen zurückgezahlt werden – wenn es für die Unternehmen und Selbstständigen in der Pandemie doch besser lief als gedacht. Mehr als 9000 Unternehmer in MV müssen nun mit hohen Rückzahlungen rechnen. Das sorgt für eine hitzige Debatte.

Donald Trump: Enthüllungen von Bob Woodward über Coronatests für Putin
www.spiegel.de | 2024-10-10 14:35:00
#putin #donaldtrump #pandemie #kremlDonald Trump hat Wladimir Putin während der Pandemie offenbar Coronatests für den Eigengebrauch gesendet. Dass der Ex-Präsident auch nach seiner Amtszeit noch mit Putin in Kontakt stand, hat der Kreml aber dementiert.

Donald Trump: Kreml bestätigt – Trump hat Wladimir Putin Corona-Tests geschickt
www.spiegel.de | 2024-10-10 14:35:00
#putin #donaldtrump #pandemie #kremlDonald Trump hat Wladimir Putin während der Pandemie offenbar Coronatests für den Eigengebrauch gesendet. Dass der Ex-Präsident auch nach seiner Amtszeit noch mit Putin in Kontakt stand, hat der Kreml aber dementiert.

Vorstoß im Kreistag Vorpommern-Rügen: MV soll Corona-Bußgelder zurückzahlen
www.ostsee-zeitung.de | 2024-10-07 16:44:00
#mecklenburgvorpommern #pandemie #afdUnterschiedliche Ansätze bei der Aufarbeitung der Pandemie: Die AfD geißelt angebliches Unrecht und übergeht den Landrat in ihrem Antrag. Zwei kleinere Fraktionen wollen hingegen differenzierter vorgehen.

Norwegische Schüler zu Gast
www.weser-kurier.de | 2024-10-07 06:02:00
#pandemieNorwegische Schüler zu Gast in Bremen-Nord: Die Oberschule Lesum belebt ein Austauschprogramm wieder, das vor der Pandemie regelmäßig stattfand. Im März fahren Lesumer Schülerinnen und Schüler nach Norwegen.

Stadt bei Hamburg plant ein Corona-Denkmal
www.abendblatt.de | 2024-10-07 05:33:00
#hamburg #pandemie #fdpErinnerung an die Pandemie schaffen. FDP greift Ansinnen einer Glinderin auf, bringt es in Ausschuss. Wo das Werk entstehen soll.

Risikokommunikation in Corona-Krise: Drosten spricht von „Umdeutung“ – stimmt das?
www.berliner-zeitung.de | 2024-10-06 06:04:59
#pandemieEigentlich gibt es Leitfäden für die öffentliche Kommunikation in Krisenzeiten. Warum haben sich Politiker und Experten während der Pandemie nicht daran gehalten?

Hermetisch abgeschottet: Auf der Insel der tödlichen Viren
www.abendblatt.de | 2024-10-04 21:09:41
#pandemieAuf der „Seucheninsel“ wird an gefährlichen Erregern geforscht. Im Kampf gegen die nächste Pandemie ist Riems wichtiger denn je.

Weniger verwaiste Kleingärten in Bremen
www.weser-kurier.de | 2024-10-03 20:29:00
#bremen #pandemieNeuer Wohnraum statt Kleingartengebiet – vor der Pandemie war diese Idee in Bremen durchaus populär. Vor allem in Gröpelingen und Walle verwilderten immer mehr Parzellen. Doch der Leerstand ist zurückgegangen.

Australien in der Glücksspielkrise: Milliardenverluste und steigende Suchtgefahr
www.ostsee-zeitung.de | 2024-10-03 10:50:15
#pandemie #australienGanz besonders während der Pandemie trieb die Langeweile die Australierinnen und Australier tiefer in die Spielsucht. Dieses Jahr sind die finanziellen Verluste, die die Bürger des Landes durch Glücksspiel machten, auf ein neues Rekordhoch geklettert. Einige wollen der Volkskrankheit den Kampf ansa…

Betrugsvorwürfe: "Querdenken"-Gründer Ballweg vor Gericht
www.tagesschau.de | 2024-10-01 18:32:56
#gericht #pandemieWährend der Pandemie organisierte er Demos gegen die Corona-Auflagen - nun muss sich der Gründer der "Querdenken"-Bewegung, Ballweg, vor Gericht verantworten. Ihm wird Steuerhinterziehung und versuchten Betrug in fast 10.000 Fällen vorgeworfen.

Von wegen mehr Digitalisierung: Corona als Bremsklotz
www.heise.de | 2024-10-01 14:16:00
#pandemie #coronaWährend der Pandemie arbeiteten zwar mehr Menschen zu Hause und waren dabei auf digitale Technik angewiesen, der Digitalisierung hat das aber nichts gebracht.

Warum eine Vogelgrippe-Pandemie unwahrscheinlich ist
www.tagesschau.de | 2024-10-01 07:05:06
#pandemie #usaSeit April grassiert beim Milchkühen in den USA das Vogelgrippe-Virus H5N1, manche Forschende fürchten die nächste humane Pandemie. Eine aktuelle Studie gibt vorsichtige Entwarnung. Von Daniela Remus.

heise+ | Digitalisierung: Warum Deutschlands Behörden immer noch faxen
www.heise.de | 2024-09-30 17:30:00
#pandemie #deutschlandIn der Pandemie geriet das Fax zum Symbol für die Rückständigkeit der deutschen Verwaltung. Nun wollen einige Politiker die Geräte aus den Amtsstuben verbannen.

Patientenschützer: Ampel macht Corona-Aufarbeitung zum „Trauerspiel“
www.ostsee-zeitung.de | 2024-09-30 06:46:08
#pandemieVieles lief in der Corona-Krise auf politischer Ebene nicht rund. Doch bei der Ampel stockt die Aufarbeitung der Pandemie. Die Deutsche Stiftung Patientenschutz geht hart mit der Regierung ins Gericht.
Folgen der Pandemie: Patientenschützer: «Trauerspiel» um Corona-Aufarbeitung
www.zeit.de | 2024-09-30 04:05:37
#pandemie
Corona: Ampel streitet über Aufarbeitung - SPD und FDP machen sich gegenseitig Vorwürfe
www.spiegel.de | 2024-09-28 14:47:00
#fdp #spd #pandemieDie Pandemie hat einen Einschnitt hinterlassen, die Coronapolitik soll aufgearbeitet werden: SPD und FDP zeigen sich davon jeweils überzeugt, werfen der jeweils anderen Partei jedoch vor, sie meine es nicht ernst genug.

Virologe Drosten über Corona: „Inzwischen sind wir in einer Situation, in der der Grippe-Vergleich zutrifft "
www.ostsee-zeitung.de | 2024-09-28 12:57:37
#pandemieChristian Drosten hält das Coronavirus mittlerweile für ähnlich gefährlich wie Grippeviren. Der Virologe nennt dafür zwei Gründe. Zu Beginn der Pandemie sei diese Einordnung aber eine Fehleinschätzung gewesen.

Christian Drosten hält Coronaviren inzwischen für nicht gefährlicher als Grippeviren
www.spiegel.de | 2024-09-28 10:08:00
#pandemieIn den ersten Jahren der Pandemie warnte der Virologe Christian Drosten eindringlich vor den Risiken einer Coronainfektion. Das sei keine Fehleinschätzung gewesen, betont er. Aber inzwischen habe sich die Lage verändert.
Folgen der Pandemie: Zwist in Koalition über Corona-Aufarbeitung
www.zeit.de | 2024-09-28 05:00:38
#pandemie
Private Krankenversicherer: Beiträge werden wohl deutlich steigen
www.spiegel.de | 2024-09-26 23:03:00
#pandemieIm Schnitt sollen die Prämien bei privaten Versicherern bald um 18 Prozent steigen. Das berichtet die »Süddeutsche Zeitung« unter Berufung auf Verbandsangaben. Grund sind demnach Folgen der Pandemie.

Manche Entscheidungen in Pandemie politisch bedingt, nicht wissenschaftlich
www.derstandard.at | 2024-09-25 13:07:01
#pandemieBei ihrem ersten Auftritt in neuer Rolle betont Pamela Rendi-Wagner die Bedeutung der Kommunikation, um in Pandemien Verunsicherung vorzubeugen. Sonst bereite man den Nährboden für Missinformation und Fake News

Fanforscher über Derby-Randale: "Mechanismen der Selbstregulierung funktionieren nicht mehr"
www.derstandard.at | 2024-09-25 09:00:00
#pandemieJonas Gabler erklärt sich zunehmende Gewalt in Fußballstadien auch mit der Pandemie. In Fangruppierungen gebe es Machtverschiebungen, dazu kommen "cani sciolti", streunende Köter

Arbeitslosigkeit: Experten prognostizieren Anstieg – besonders Industrie betroffen
www.ostsee-zeitung.de | 2024-09-23 11:56:26
#pandemieDie Beschäftigung steigt kaum noch, besonders für die Industrie sieht es schlecht aus, sehen Expertinnen und Experten voraus. Auch die Pandemie scheint noch immer Folgen zu haben, seitdem haben sich die Jobchancen von Arbeitslosen noch immer nicht vollends erholt.

Corona-Ursprung durch Wildtierhandel in China? Neue Hinweise durch Studie
www.berliner-zeitung.de | 2024-09-20 11:29:45
#pandemie #coronaEine Studie sieht Indizien, dass die Pandemie durch Zoonose entstand. Die Labor-Theorie entkräftet sie nicht. Das sagen Charité-Virologe Christian Drosten und andere.

Corona-Impfpflicht: "In die Verfassungswidrigkeit hineingewachsen"
www.tagesschau.de | 2024-09-19 17:37:58
#pandemieSchon während der Pandemie gab es Kritik an der einrichtungsbezogenen Impfpflicht. Ein Gericht kommt nun zum Ergebnis: Die Regelung sei im Laufe des Jahres 2022 verfassungswidrig geworden. Der Beschluss liegt dem ARD-Hauptstadtstudio vor. Von N. Bader.

»Pokémon«-Sammelkartenspiel-Pocket: Was Sie vorab über das neue Spiel wissen sollten
www.spiegel.de | 2024-09-19 14:59:00
#pandemie»Pokémon Go« war ein globaler Hit, »Pokémon«-Karten haben in der Pandemie ein Revival erlebt. Nun könnte eine Kartensammel-App den Hype fortsetzen. Für große Fans lauert hier eine Sucht- und Kostenfalle.

Corona-Selbsttest abgelaufen: Kann ich ihn noch nutzen?
www.ostsee-zeitung.de | 2024-09-19 14:02:43
#pandemieIn vielen Haushalten finden sich nach der Pandemie noch ungenutzte Corona-Selbsttests. Doch meist ist das Verfallsdatum auf der Verpackung schon längst überschritten. Kann man die Tests noch verwenden oder sollte man sie lieber entsorgen? Das raten Experten.
Pandemie: BSW will Corona-Untersuchungsausschuss beantragen
www.zeit.de | 2024-09-19 13:48:36
#bsw #pandemieLandtagswahl in Brandenburg: Dietmar Woidke setzt alles auf Sieg
www.zeit.de | 2024-09-19 05:58:01
#landtagswahl #spd #pandemie #brandenburgDer brandenburgische Ministerpräsident will nur weitermachen, wenn die SPD bei der Landtagswahl siegt. Und: Kinder und Jugendliche leiden noch immer unter der Pandemie.

Corona-Pandemie: Gesundheitliche Folgen sind immer noch spürbar
www.spiegel.de | 2024-09-18 14:57:00
#pandemieAngst, Depressionen, Bewegungsmangel: Vor allem Kinder, Jugendliche und Mütter haben unter der Pandemie gelitten – und tun dies teilweise bis heute. Eine aktuelle Studie zeigt das Ausmaß.

Antibiotika-Resistenzen: Bis 2050 könnten 40 Millionen Menschen sterben
www.spiegel.de | 2024-09-17 14:59:00
#pandemieBereits heute sterben jährlich über eine Million Menschen an resistenten Bakterien, gegen die Antibiotika machtlos sind. Forschende warnen ob der Prognose für die kommenden Jahre vor einer »übersehenen Pandemie«.

VW-Aktie: Jetzt kaufen – oder besser schnell verkaufen?
www.abendblatt.de | 2024-09-17 13:00:00
#pandemieDieselskandal, Pandemie – und nun das Sparprogramm: Die Volkswagen-Aktie hat turbulente Zeiten hinter sich. Wie geht es weiter?

Der Staat hat keinen Kredit mehr
www.derstandard.at | 2024-09-13 05:00:00
#österreich #pandemieÖsterreichs Staatsausgaben steigen wie in den schlimmsten Krisenzeiten, und das Budgetdefizit ist derzeit größer als zu Zeiten der Pandemie. Hoffnungen, das Problem über magische Vermögenssteuern zu lösen, sind eine Illusion
Gehirne von Jugendlichen: Wie die Pandemie auf jugendliche Gehirne wirkte
www.zeit.de | 2024-09-09 21:00:09
#pandemieÄngste, Depressionen, Essstörungen: Die Pandemie hat Jugendlichen aufs Gemüt geschlagen. Eine neue Studie zeigt nun: Sogar ihre Gehirne alterten schneller. Was ist dran?

Sandra Hertlein vom FeM Mädchen*haus: »Wir haben uns mit einem Hilfeschrei an die Politik gewandt«
www.spiegel.de | 2024-09-08 11:18:00
#pandemie #frankfurtSandra Hertlein arbeitet im FeM Mädchen*haus in Frankfurt am Main. Seit der Pandemie ist die Nachfrage gestiegen, bei gleichzeitig weniger Personal. Die Sozialpädagogin sorgt sich um den Schutz der Minderjährigen.

Hendrik Streeck: Warum der Virologe für die CDU in den Bundestag will
www.spiegel.de | 2024-09-07 14:35:00
#bundestag #pandemie #cduIn der Pandemie war er als Wissenschaftler gefragt und umstritten, galt als Gegenspieler von Christian Drosten. Nun kandidiert Hendrik Streeck für den Bundestag. Unserem Reporter hat er erzählt, warum.

Vogelgrippe: Erstmals Mensch ohne Kontakt zu Tieren an der Vogelgrippe erkrankt
www.spiegel.de | 2024-09-07 11:36:00
#pandemieIm US-Bundesstaat Missouri hat sich eine Person mit dem Vogelgrippe-Virus H5N1 infiziert, ohne mit Tieren in Berührung gekommen zu sein.

OZ-Leser zweifeln am Willen zur Corona-Aufarbeitung: „Politiker müssen ihre Fehler eingestehen“
www.ostsee-zeitung.de | 2024-09-04 11:16:05
#deutschland #pandemie #rostockDer SPD-Gesundheitsminister Karl Lauterbach bescheinigt Deutschland, „sehr gut durch die Pandemie“ gekommen zu sein. Der Rostocker Kunsthallenchef Jörg-Uwe Neumann und einige OZ-Leser sehen das ganz anders.

Mpox-Ausbruch in Afrika: »Der Kontinent ist nicht bereit für eine neue Pandemie«
www.spiegel.de | 2024-08-31 09:50:00
#pandemieSeit Wochen breitet sich eine neue Mpox-Variante in Afrika aus. Die Epidemie gilt als internationaler Gesundheitsnotfall. In den überfüllten Geflüchtetencamps der Demokratischen Republik Kongo stecken sich besonders viele Kinder an.

Mpox-Ausbruch in Afrika: »Der Kontinent ist nicht vorbereitet auf eine neue Pandemie«
www.spiegel.de | 2024-08-31 09:50:00
#pandemieSeit Wochen breitet sich eine neue Mpox-Variante in Afrika aus. Die Epidemie gilt als internationaler Gesundheitsnotfall. In den überfüllten Geflüchtetencamps der Demokratischen Republik Kongo stecken sich besonders viele Kinder an.

Landesregierung MV lagert noch Millionen Corona-Masken – Was damit passiert
www.ostsee-zeitung.de | 2024-08-31 09:31:55
#pandemie #mecklenburgvorpommernCorona-Schutzmasken waren in der Pandemie für viele Bereiche notwendig. In Lagern des Landes befinden sich noch rund 2,7 Millionen Stück – deutlich weniger als noch vor einem Jahr.

Rostocks Kunsthallen-Chef fordert Aufarbeitung der Corona-Pandemie
www.ostsee-zeitung.de | 2024-08-28 10:18:45
#pandemie #greifswald #rostock #schwerinWarum mussten Museen für so lange Zeit geschlossen werden? Diese Frage will der Chef der Rostocker Kunsthalle, Jörg-Uwe Neumann, gern beantwortet bekommen. Denn auch in Schwerin und Greifswald habe die Pandemie langfristige Folgen bei den Kultureinrichtungen hinterlassen. Das dürfe sich nicht wiede…

Mark Zuckerberg beklagt Zensur während der Pandemie
www.derstandard.at | 2024-08-27 16:37:27
#pandemieDer Meta-Chef berichtet in einem Brief an den Justizausschuss des US-Repräsentantenhauses von Druck "hoher Beamter", Inhalte zur Corona-Pandemie zu zensieren

Facebook: Corona-Inhalte wurden auf Druck des Weißen Hauses zensiert
www.berliner-zeitung.de | 2024-08-27 08:25:27
#pandemieZuckerberg sagt, Facebook sei während der Pandemie „unter Druck gesetzt“ worden, Inhalte zu zensieren. Er bedauere, dass er sich den Forderungen gebeugt habe.

Corona und Übersterblichkeit: Warum die Impfstoffe als Ursache nicht auszuschließen sind
www.berliner-zeitung.de | 2024-08-27 05:55:14
#corona #pandemie #englandDaten aus England zeigen: Die Nicht-Covid-19-Sterblichkeit war bei Geimpften in der Pandemie teils deutlich höher als bei Ungeimpften. Warum wird das nicht weiter untersucht?

Corona: Hört auf, unser Geld aus dem Fenster zu werfen
www.abendblatt.de | 2024-08-24 12:01:15
#pandemie #coronaBeim Kauf von Masken, Impfdosen oder Medikamenten: In der Pandemie hat die Politik schlecht gewirtschaftet. Das kommt uns teuer zu stehen.

Bremer Steuerzahler brauchen weiter Geduld
www.weser-kurier.de | 2024-08-24 05:33:00
#bremen #pandemieEs kann lange dauern, bis Steuerpflichtige aus Bremen vom Finanzamt hören. Als Grund nennt die Behörde personelle Engpässe und Nachwirkungen der Pandemie. Es gibt aber auch Licht am Ende des Tunnels.

Wie gefährlich ist Mpox?
www.derstandard.at | 2024-08-21 17:32:30
#pandemieJetzt anhören: Früher als Affenpocken bekannt, hat die Erkrankung Mpox jetzt zu einem weltweiten Gesundheitsnotstand geführt. Droht die nächste Pandemie?

Lebenserwartung steigt nach Pandemie erstmals wieder
www.tagesschau.de | 2024-08-21 10:26:28
#deutschland #pandemieDie durchschnittliche Lebenserwartung in Deutschland ist wieder gestiegen. Statistiker sprechen nach der Corona-Pandemie von einem "deutlichen Aufholeffekt". Unterschiede gibt es jedoch zwischen Ost und West.

"Campingurlaub ist weder unhygienisch noch unbequem"
www.weser-kurier.de | 2024-08-20 05:00:00
#pandemieDie Pandemie hat der Campingbranche mächtig Auftrieb verschafft. Was eingeschworene Camper vom Zulauf und neuen Trends halten, weiß der Vorsitzende des Camping Club Bremen.

Drogenkonsum während Pandemie hat langfristige Folgen
www.derstandard.at | 2024-08-19 12:41:58
#pandemieDie Pandemie war für viele psychisch belastend, ganz besonders für Kinder und Jugendliche. Zu Beginn hat der Substanzgebrauch bei jungen Menschen dennoch abgenommen – vorerst

Singen im Chor: Immer mehr Menschen entdecken die Lust am gemeinsamen Singen
www.ostsee-zeitung.de | 2024-08-18 11:42:24
#pandemieViele Chöre mussten während der Pandemie aufgeben. Doch nun zeichnet sich eine Trendwende ab. Besonders in den Städten erleben Chöre mit innovativen Konzepten viel Zulauf.

Chöre nach Corona: Immer mehr Menschen entdecken die Lust am gemeinsamen Singen
www.ostsee-zeitung.de | 2024-08-18 10:36:40
#pandemie #coronaViele Chöre mussten während der Pandemie aufgeben. Doch nun zeichnet sich eine Trendwende ab. Besonders in den Städten erleben Chöre mit innovativen Konzepten viel Zulauf.

Maidesite T4 Pro Plus: Höhenverstellbarer Schreibtisch ausprobiert
stadt-bremerhaven.de | 2024-08-17 08:30:45
#pandemieDas Homeoffice ist zu Zeiten der Pandemie modern geworden und etliche Unternehmen stützten sich auf die Möglichkeit, auch Mitarbeiter fernab des Büros produktiv arbeiten zu lassen. Mittlerweile rudern viele Unternehmen wieder zurück und wollen ihre Leute wieder im Büro sehen....

Wie gefährlich ist der Mpox-Virus?
www.derstandard.at | 2024-08-16 17:29:30
#pandemieDie WHO hat aufgrund einer neuen Variante eine weltweite Notlage ausgerufen. Das soll Behörden alarmieren, aber von einer Pandemie ist man weit entfernt, sind sich Fachleute einig

Google Fitbit und Peloton kündigen Partnerschaft an
stadt-bremerhaven.de | 2024-08-16 12:30:55
#pandemieDer Fitnessanbieter Peloton hat es in den vergangenen Jahren nicht unbedingt leicht gehabt. Nachdem man während der Pandemie einen Aufschwung erlebt hatte, kämpft man seitdem mit Problemen und mehr oder minder auch ums Überleben. Das Unternehmen versucht daher, seine Services...

China ist der weltgrößte Emittent, nun aber sinken die CO₂-Emissionen. Kann das von Dauer sein?
www.derstandard.at | 2024-08-15 06:00:00
#china #pandemieIm zweiten Quartal 2024 waren die Emissionen des Energiesektors erstmals seit der Pandemie rückläufig. Ob es so weitergeht, ist fraglich – nicht nur ob des rasanten Ausbaus der Kohlekraftwerke

Bringt die Sommerhitze die Menschen zurück ins Büro?
www.derstandard.at | 2024-08-15 06:00:00
#pandemieMit der Pandemie hat sich in den meisten Unternehmen das Homeoffice etabliert. Damit ist es in so manchem Büro recht leer geworden

Lauterbach: „Das war der zentrale Fehler der Pandemie“
www.abendblatt.de | 2024-08-14 21:00:00
#pandemieDer Gesundheitsminister spricht über Entscheidungen in der Corona-Politik – und warnt davor, das Virus im Nachhinein zu verharmlosen.

Corona-Spürhunde hätten in der Pandemie viel verändern können, wurden aber kaum genutzt: warum?
www.berliner-zeitung.de | 2024-08-12 14:53:21
#deutschland #pandemieHunde, die Leben retten könnten: Warum Corona-Spürhunde in Deutschland nicht eingesetzt wurden, trotz beeindruckender Ergebnisse.

Japan will mit verschiedenen Mitteln Overtourism verhindern
www.tagesschau.de | 2024-08-12 12:00:04
#japan #pandemieSeit dem Ende der Pandemie kommen immer mehr Touristen nach Japan. Die sind durchaus willkommen, doch das Verhalten der Besucher sorgt für Unmut. Das Land hat nun Maßnahmen ergriffen - auch um Overtourism zu verhindern. Von K. Erdmann.

Hendrik Streeck im Bundestag: Wie der Virologe für die CDU die Pandemie aufarbeiten möchte
www.ostsee-zeitung.de | 2024-08-10 23:27:47
#pandemie #cdu #politik #bundestagEr ist einer der bekanntesten Wissenschaftler aus Zeiten der Pandemie. Jetzt hat Hendrik Streeck ein neues Ziel vor Augen: Für die CDU in den Bundestag ziehen. Ein Gespräch über das Verhältnis zwischen Politik und Wissenschaft, die Aufarbeitung der Pandemie und das Bedürfnis nach Geborgenheit.

Tourismus in Berlin: Wieder mehr Übernachtungen
www.berliner-zeitung.de | 2024-08-09 14:39:58
#berlin #corona #pandemieDer Tourismus hat in Berlin seit der Pandemie wieder deutlich angezogen. Trotzdem werden Zahlen wie vor Corona noch nicht wieder erreicht.

Reich, reicher, am reichsten: Mehr Einkommensmillionäre in Hamburg
www.abendblatt.de | 2024-08-07 13:14:10
#hamburg #pandemieNach der jüngsten Statistik verdienten zuletzt 1304 Menschen mindestens siebenstellig. Seit Jahren werden es mehr – auch in der Pandemie.

Elf Dinge, die wir über Covid gelernt haben
www.derstandard.at | 2024-08-07 12:00:00
#pandemieDie Nachbearbeitung der Pandemie und der daraus gezogenen Erkenntnisse ist immer noch in vollem Gange, medizinisch, aber auch gesellschaftlich. Ein Überblick über elf Teilbereiche

Was ist aus den "Stars" der Corona-Zeit geworden?
www.tagesschau.de | 2024-08-06 10:05:32
#pandemieDas Mainzer Unternehmen BioNTech kennt seit der Pandemie jeder. Doch inzwischen ist es ruhig geworden um den Biotech-Konzern. Dabei arbeitet das Unternehmen im Hintergrund fleißig weiter. Von Alina Leimbach.

Natalie Grams über Long Covid: »Sind nicht alle Frauen erschöpft? Das verkennt krass die Schwere der Krankheit«
www.spiegel.de | 2024-08-06 06:34:00
#pandemieAls Ärztin kannte Natalie Grams ME/CFS schon vor der Pandemie. Berichte über die Krankheit erschütterten sie, ließen sie aber auch leicht zweifeln: Kann das stimmen? Heute leidet sie selbst an Long Covid – und kritisiert Ärzte.

Was könnte die nächste Pandemie auslösen?
www.derstandard.at | 2024-08-05 17:58:33
#pandemieDie WHO hat die Liste der gefährlichsten Viren und Erreger aktualisiert. Neu dabei ist Mpox: Eine tödlichere Variante der "Affenpocken" breitet sich derzeit in Zentralafrika aus

Berlin: »Querdenker« demonstrieren nach vier Jahren wieder
www.spiegel.de | 2024-08-03 19:57:00
#berlin #pandemieDie Pandemie ist längst beendet, doch am Samstag zogen einmal mehr Tausende Impfgegner durch Berlin. Einige ihrer Forderungen sind altbekannt, andere neu.

Generation Lockdown: Jugend in Europa ohne Arbeit
www.berliner-zeitung.de | 2024-08-02 22:41:19
#europa #pandemieDie Jugendarbeitslosigkeit ist nach der Pandemie in einigen Ländern sehr hoch. Nicht nur der Süden Europas ist betroffen.

Inlandtourismus: Eine Branche ächzt unter Personalmangel
www.ostsee-zeitung.de | 2024-08-02 09:25:30
#deutschland #urlaub #pandemieBereits der Mai brach Rekorde: Hotels, Pensionen und Campingplätze zählten wieder mehr Übernachtungen als vor der Pandemie. Urlaub in Deutschland ist angesagt – allerdings steht die Branche vor einigen Herausforderungen.

Die Grünen wollen Recht auf Homeoffice – besonders für Frauen
www.ostsee-zeitung.de | 2024-08-01 10:08:27
#diegrünen #pandemieIn der Pandemie gab es kaum eine andere Möglichkeit als von zu Hause aus zu arbeiten. Heute möchten manche nicht mehr darauf verzichten. Und die Grünen fordern nun sogar ein Recht auf Homeoffice. Unterstützung bekommen sie von den Gewerkschaften.

Grüne wollen Recht auf Homeoffice – besonders für Frauen
www.ostsee-zeitung.de | 2024-08-01 07:38:20
#pandemie #diegrünenIn der Pandemie gab es kaum eine andere Möglichkeit als von zu Hause aus zu arbeiten. Heute möchten manche nicht mehr darauf verzichten. Und die Grünen fordern nun sogar ein Recht auf Homeoffice. Unterstützung bekommen sie von den Gewerkschaften.

Hohe Treibstoffpreise und Personalkosten belasten Lufthansa-Bilanz
www.tagesschau.de | 2024-07-31 12:50:59
#pandemieDie Lufthansa macht wieder Geschäfte wie vor der Pandemie. Der Umsatz ist auf altem Niveau, die Schulden liegen sogar niedriger. Hohe Treibstoffpreise und Personalkosten belasten aber die Bilanz. Von Ingo Nathusius.

Vogelgrippe: Gefahr für Menschen und potenzielle Pandemie? – Podcast
www.spiegel.de | 2024-07-30 19:00:00
#corona #pandemieDie Vogelgrippe befällt Kühe, Katzen und vereinzelt sogar Menschen. Wie gefährlich ist das Virus, und wie unterscheidet es sich von Corona? SPIEGEL-Redakteurin Alina Schadwinkel klärt auf.

Vogelgrippe: Gefahr für Menschen und potenzielle Pandemie? – Podcast
www.spiegel.de | 2024-07-30 16:24:00
#corona #pandemieDie Vogelgrippe befällt Kühe, Katzen und vereinzelt sogar Menschen. Wie gefährlich ist das Virus, und wie unterscheidet es sich von Corona? SPIEGEL-Redakteurin Alina Schadwinkel klärt auf.

Wien abseits der ausgetrampelten Pfade: Es soll Touristen an den Stadtrand ziehen
www.derstandard.at | 2024-07-30 15:00:00
#wien #pandemieDer Stephansdom und Schönbrunn sind touristische Selbstläufer. Doch in Wien will man Gäste aus dem Ausland verstärkt zu unbekannteren Spots lotsen. Die Pandemie ist jedenfalls abgehakt

Vogelgrippe: „Wir haben Impfstoffe, die zugelassen sind“
www.abendblatt.de | 2024-07-30 11:49:13
#pandemie #coronaExperten warnen vor einer möglichen Pandemie mit H5N1. Anders als bei Corona gibt es schon Impfstoffe – und neue sind in der Entwicklung.

In diesem Traditionsgeschäft kaufen Taylor-Swift-Fans ein
www.abendblatt.de | 2024-07-30 04:35:00
#pandemie #hamburg #sommerWie ein kultiger Hamburger Hutladen in der City die Pandemie überstand – und welche Hüte im Sommer 2025 angesagt sein werden.

EuGH-Urteil zu Pandemiefolgen: Veranstalter pleite - und doch Geld zurück
www.tagesschau.de | 2024-07-29 17:58:07
#pandemieDer Europäische Gerichtshof hat die Rechte von Urlaubern gestärkt, die von der Pandemie betroffen waren - und danach von einer Veranstalterpleite. Verbraucherschützer begrüßen das Urteil. Von E. Hyseni und P. Raillon.
Europäischer Gerichtshof: Ryanair scheitert mit Klage gegen Coronahilfen für Lufthansa-Tochter
www.zeit.de | 2024-07-29 12:26:24
#pandemieIn der Pandemie hatten einige Flugbetreiber staatliche Hilfen erhalten – Ryanair klagte dagegen. Zahlungen an die Austrian Airlines waren aber rechtens, urteilt der EuGH.

150 Millionen Euro vom Staat für AUA – EU-Gerichtshof erklärt Corona-Hilfen für zulässig
www.derstandard.at | 2024-07-29 10:41:15
#pandemieDie Austrian Airlines hatten im Zuge der Pandemie ein großzügiges Hilfspaket von der Regierung bekommen. Ryanair klagte, blieb jedoch erfolglos

150 Millionen Euro vom Staat für die AUA: EU-Gerichtshof bestätigt Corona-Hilfen
www.derstandard.at | 2024-07-29 10:41:15
#pandemieDie AUA hatte im Zuge der Pandemie ein großzügiges Hilfspaket von der Regierung bekommen. Ryanair klagte, blieb jedoch erfolglos

Gestorben auf der Intensivstation: Wie gefährlich sind maschinelle Beatmungen?
www.berliner-zeitung.de | 2024-07-28 06:11:47
#pandemie #coronaWährend Corona galten maschinelle Beatmungen und das Ecmo-Verfahren oft als Heilmethoden. Eine neue Studie zeigt jedoch: Die Sterbezahlen sind auch außerhalb der Pandemie erschreckend hoch.

RKI-Corona-Dokumente: Welche Frage eine Aufarbeitung verlangt
www.ostsee-zeitung.de | 2024-07-26 15:04:42
#pandemieIm Streit über die Impfpolitik wiederholt sich die gleiche Diskussion wie zu Pandemie-Hochzeiten. Die demokratischen Parteien sollten sich zu einer Enquete-Kommission durchringen, um die Deutungshoheit nicht den Verschwörungsideologen zu überlassen, meint Alisha Mendgen.

„Pandemie der Ungeimpften“ - Welche Frage eine Aufarbeitung verlangt
www.ostsee-zeitung.de | 2024-07-26 13:01:25
#pandemieIm aktuellen Streit über die Impfpolitik wiederholt sich die gleiche Diskussion wie zu Hochzeiten der Pandemie. Die demokratischen Parteien sollten sich zu einer Enquete-Kommission durchringen, um die Deutungshoheit nicht den Verschwörungsideologen zu überlassen, kommentiert Alisha Mendgen.

Corona-Aufarbeitung: Ein Virus namens Wurstigkeit - Kolumne
www.spiegel.de | 2024-07-26 13:00:00
#pandemieWären wir auf eine neue Pandemie vorbereitet? Nicht, solange die alte nicht aufgearbeitet wird. Doch die Verantwortlichen sind zu feige oder zu eitel.

Corona: Bundesgericht bestätigt Ladenschließungen während Pandemie
www.ostsee-zeitung.de | 2024-07-25 20:29:44
#corona #pandemieIn der Corona-Frühphase durften Läden mit mehr als 800 Quadratmeter Fläche nicht öffnen. Das Bundesverwaltungsgericht hat diese Größenbegrenzung nun bestätigt.

Bundesgericht weist Klage gegen Coronaregeln ab
www.spiegel.de | 2024-07-25 18:04:00
#pandemieZu Beginn der Pandemie mussten Geschäfte mit mehr als 800 Quadratmetern Verkaufsfläche knapp zwei Wochen schließen. Das Bundesverwaltungsgericht hält diese Maßnahme für angemessen.

RKI-Files komplett entschwärzt: „Pandemie der Ungeimpften aus fachlicher Sicht nicht korrekt“
www.berliner-zeitung.de | 2024-07-23 14:51:58
#pandemieEs war das größte Narrativ der Pandemie, fast weltweit verkündet: Mit der Offenlegung der komplett entschwärzten RKI-Files wird die „Pandemie der Ungeimpften“ enttarnt – als Lüge.
Großbritannien: Britische Polizei warnt vor starkem Anstieg der Gewalt gegen Frauen
www.zeit.de | 2024-07-23 12:10:51
#pandemie #england #großbritannienJeden Tag werden allein in England und Wales etwa 3.000 Fälle von Gewalt gegen Frauen und Mädchen gemeldet. Vor der Pandemie waren die Zahlen um 37 Prozent niedriger.
